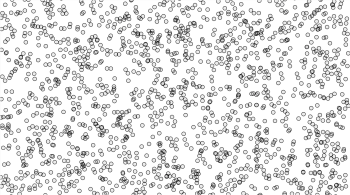
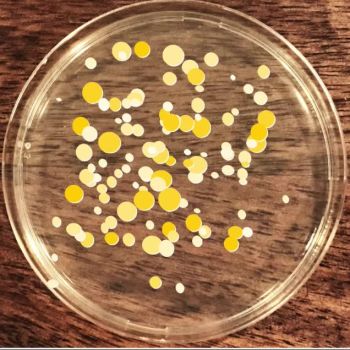

Comp Form Sketches 2017

Dorothy Cruz
77 sketches

Talia Cotton
75 sketches

S. I.
74 sketches

Sachi Chandiramani
73 sketches

Jonathan Kho
73 sketches

Danielle Sobel
72 sketches

Bateel Saber
71 sketches

Amber Chen
71 sketches

Enayet Kabir
69 sketches

Jane Lee
65 sketches

Jennifer Lee
64 sketches

Kim Koehler
57 sketches

Gabriel Mester
52 sketches

Aaron Lee
6 sketches

Brinna Thomsen
6 sketches

Lauren Donohue
2 sketches
S. I.
1 sketches

Chao Tu
1 sketches
Aimee Abalos
1 sketches

Terricka Johnson
1 sketches
Sahiti Agarwal
0 sketches

Justin Bakse
7 sketches
Tile Graphics
85
Random Values
74
Config Parameters
65
Using Noise
62
CF Strategies
67
Generating Animation
61
Processing Pixels
72
Turtle Graphics
76
Node Programming
22
Vector Data
94
Generating Text
68
Comp Sound
56
3D Forms
65
Micro Games
51

Using xpresso in C4D to animate the position of the falloff box for different deformers to warp t…
 Enayet KabirMay 20 at 6:26 AM
Enayet KabirMay 20 at 6:26 AM

sketch to change geometry into voxels, apply booleans with voxels, and then convert back into geo…
 Enayet KabirMay 20 at 6:24 AM
Enayet KabirMay 20 at 6:24 AM
learning this technique. played with changing the bounding shape from a sphere to an ellipsoid.
 Enayet KabirMay 20 at 6:22 AM
Enayet KabirMay 20 at 6:22 AM

simple l-system in houdini utilizing the attach geometry feature
 Enayet KabirMay 20 at 6:21 AM
Enayet KabirMay 20 at 6:21 AM
using xpresso in cinema 4d to sync up the ipad swiping with the screen surface movement
 Enayet KabirMay 20 at 6:21 AM
Enayet KabirMay 20 at 6:21 AM
working on comp form text reveals
 Enayet KabirMay 20 at 6:20 AM
Enayet KabirMay 20 at 6:20 AM
working on comp form text reveals
 Enayet KabirMay 20 at 6:20 AM
Enayet KabirMay 20 at 6:20 AM
working on comp form text reveals
 Enayet KabirMay 20 at 6:20 AM
Enayet KabirMay 20 at 6:20 AM
working on comp form text reveals
 Enayet KabirMay 20 at 6:19 AM
Enayet KabirMay 20 at 6:19 AM
working on comp form text reveals
 Enayet KabirMay 20 at 6:18 AM
Enayet KabirMay 20 at 6:18 AM
Updated—now that I can record my sound.
 Gabriel MesterMay 16 at 3:58 AM
Gabriel MesterMay 16 at 3:58 AM
Finally found an alternative to SoundFlower, which no longer seems to work on my computer. Kind…
 Gabriel MesterMay 16 at 2:30 AM
Gabriel MesterMay 16 at 2:30 AM
Making a rock bed texture to apply to 3d models.
 Enayet KabirMay 15 at 11:23 PM
Enayet KabirMay 15 at 11:23 PM
More experiments with tiling patterns.
 Enayet KabirMay 15 at 11:22 PM
Enayet KabirMay 15 at 11:22 PM
Experimenting with textures to use on 3d models.
 Enayet KabirMay 15 at 11:21 PM
Enayet KabirMay 15 at 11:21 PM
 Enayet KabirMay 15 at 11:21 PM
Enayet KabirMay 15 at 11:21 PM


Got a version closer to what I wanted for my Thesis 1 draft. Was trying to get something like the…
 Gabriel MesterMay 15 at 9:05 PM
Gabriel MesterMay 15 at 9:05 PM
Maya scripting from 3D week..
 Kim KoehlerMay 15 at 3:52 AM
Kim KoehlerMay 15 at 3:52 AM


I created this during tile graphics week. But every tile is to heavy so I couldnt finish it becau…
 Kim KoehlerMay 14 at 3:38 AM
Kim KoehlerMay 14 at 3:38 AM
// press space when the two circles are the same size ! // wanted to make the black circle's…

Didnt rreally turn out the way I predicted. Used the center of the sprites for collision detectio…
 Kim KoehlerMay 14 at 1:44 AM
Kim KoehlerMay 14 at 1:44 AM
Definitely the project I worked on most during the semester. Glad I got it working at last. I pul…
 Kim KoehlerMay 14 at 1:40 AM
Kim KoehlerMay 14 at 1:40 AM
"The chosen one"—Only one head can be the president. Find which one. (Featuring a prot…
 Gabriel MesterMay 12 at 7:45 PM
Gabriel MesterMay 12 at 7:45 PM
I've been having a hard time with the code this week, and this game is not my code. I got hel…
 Sachi ChandiramaniMay 12 at 7:06 PM
Sachi ChandiramaniMay 12 at 7:06 PM
Catch the princess, watch out for Bowser!
 Kim KoehlerMay 12 at 7:04 PM
Kim KoehlerMay 12 at 7:04 PM
When you use the mousePressed the rain drop will fall (velocity) and you have to control it with…
 Danielle SobelMay 12 at 6:37 PM
Danielle SobelMay 12 at 6:37 PM
 Bateel SaberMay 12 at 6:15 PM
Bateel SaberMay 12 at 6:15 PM
 Bateel SaberMay 12 at 4:27 PM
Bateel SaberMay 12 at 4:27 PM
Group Collisions
 Danielle SobelMay 12 at 3:23 PM
Danielle SobelMay 12 at 3:23 PM
Too many finals & help from:
 Danielle SobelMay 12 at 2:54 PM
Danielle SobelMay 12 at 2:54 PM
Running game. Get to the finish before the other weird Yoshis. (You are the original.) The other…
 Kim KoehlerMay 12 at 11:29 AM
Kim KoehlerMay 12 at 11:29 AM
Had a lot of fun making those, so I created 4 more :D
 Kim KoehlerMay 12 at 11:28 AM
Kim KoehlerMay 12 at 11:28 AM
I created a couple of pixelstyle cameleon Yoshis to use as sprites for my mini games.
 Kim KoehlerMay 12 at 11:26 AM
Kim KoehlerMay 12 at 11:26 AM
This is more of a self reflection kinda game, mostly about the environment. There is a hidden eas…
 Enayet KabirMay 12 at 9:08 AM
Enayet KabirMay 12 at 9:08 AM
Ball (player) can only strafe from side to side while the obstacles are moving towards you. I thi…
 Enayet KabirMay 12 at 9:06 AM
Enayet KabirMay 12 at 9:06 AM
You can't sit with us
 Enayet KabirMay 12 at 9:02 AM
Enayet KabirMay 12 at 9:02 AM
Feed Nic Cage!!
 Enayet KabirMay 12 at 9:01 AM
Enayet KabirMay 12 at 9:01 AM
Shooting game
 Enayet KabirMay 12 at 9:01 AM
Enayet KabirMay 12 at 9:01 AM
Finally got it to skid after being pushed by the peasant!!
 Jonathan KhoMay 12 at 6:27 AM
Jonathan KhoMay 12 at 6:27 AM
Tap. Tap. Tap.
 Amber ChenMay 12 at 6:16 AM
Amber ChenMay 12 at 6:16 AM
TALIA: THANK YOU !! THAT WORKED !!
Got it to work where you have to push the king to feed…
 Jonathan KhoMay 12 at 5:42 AM
Jonathan KhoMay 12 at 5:42 AM

Two Player Game.
If you get shot you lose a point.
But also if you shoot you lose a…
 Talia CottonMay 12 at 5:27 AM
Talia CottonMay 12 at 5:27 AM
 Bateel SaberMay 12 at 4:34 AM
Bateel SaberMay 12 at 4:34 AM
JONATHAN: You probably figured it out by now but this is a really primitive way to solve your pro…
 Talia CottonMay 12 at 4:24 AM
Talia CottonMay 12 at 4:24 AM
Feed your king. If you don't, he will shrink off into a pixel and die. If you feed him more h…
 Jonathan KhoMay 12 at 4:16 AM
Jonathan KhoMay 12 at 4:16 AM

GET IN MA BELLEH!
I think the one polishing move would be to add a timer. If…
 Talia CottonMay 12 at 4:12 AM
Talia CottonMay 12 at 4:12 AM
Stack your dango with your keyboard and mouseX.
 Amber ChenMay 12 at 3:17 AM
Amber ChenMay 12 at 3:17 AM
As was trying to replicate this delay for when the sprite is following my mouse position.
 Jonathan KhoMay 12 at 3:08 AM
Jonathan KhoMay 12 at 3:08 AM
Shepard Simulator feat. Those familiar sheep graphics from week 2 | Shoutout to Talia for the sco…
 Amber ChenMay 12 at 3:01 AM
Amber ChenMay 12 at 3:01 AM
WIP: Why... :'D
Accidentally shifted it from setup() to draw().
 Jonathan KhoMay 12 at 2:18 AM
Jonathan KhoMay 12 at 2:18 AM
So, the spider is too big or the squares are too big, but sometimes the spider gets stuck! It als…
 Sachi ChandiramaniMay 12 at 2:02 AM
Sachi ChandiramaniMay 12 at 2:02 AM


Why did the chicken cross the road? #fail
 Dorothy CruzMay 11 at 8:50 PM
Dorothy CruzMay 11 at 8:50 PM
Wasn't supposed to get too political, take it with a grain of salt 😬
 Sachi ChandiramaniMay 11 at 8:35 PM
Sachi ChandiramaniMay 11 at 8:35 PM
So, my intention was to have this be a two color game, where you have to keep clicking until one…
 Sachi ChandiramaniMay 11 at 7:22 PM
Sachi ChandiramaniMay 11 at 7:22 PM
get the ball in the target!
click activates "drop".
target moves po…
 Talia CottonMay 11 at 6:06 PM
Talia CottonMay 11 at 6:06 PM
AMBER & SANIE (And anyone else who was having trouble with the "counter") --
 Talia CottonMay 11 at 4:29 PM
Talia CottonMay 11 at 4:29 PM
'Cause if you liked it, then you shoulda put a 💍 on it 🎶 I did this on After Effects.
<… Dorothy CruzMay 11 at 4:25 PM
Dorothy CruzMay 11 at 4:25 PM
 Jane LeeMay 11 at 9:17 AM
Jane LeeMay 11 at 9:17 AM
Wish I have a dog...T T
 Jane LeeMay 11 at 8:51 AM
Jane LeeMay 11 at 8:51 AM
Make popcorn as much as you want
 Jane LeeMay 11 at 8:38 AM
Jane LeeMay 11 at 8:38 AM
bone:
 Jane LeeMay 11 at 8:22 AM
Jane LeeMay 11 at 8:22 AM
 Jane LeeMay 11 at 8:09 AM
Jane LeeMay 11 at 8:09 AM
 Bateel SaberMay 11 at 5:13 AM
Bateel SaberMay 11 at 5:13 AM
The heads have to be pushed in order to get one to touch the crown and become the president (Aler…
 Gabriel MesterMay 10 at 10:50 PM
Gabriel MesterMay 10 at 10:50 PM

A major fail for sketch 1. I spent a while trying to get these smiley's to randomly appear, a…
 Sachi ChandiramaniMay 10 at 9:30 PM
Sachi ChandiramaniMay 10 at 9:30 PM

Help the toys find their owners.
For making this more challenging I would:
- M…
 Dorothy CruzMay 10 at 8:35 PM
Dorothy CruzMay 10 at 8:35 PM
"Step in the arena" — French elections special feat. fist from May 68 poster
 Gabriel MesterMay 10 at 6:58 PM
Gabriel MesterMay 10 at 6:58 PM
Update Using Noise: Pixel processing with noise over a halftoned shape.
 Gabriel MesterMay 10 at 3:02 AM
Gabriel MesterMay 10 at 3:02 AM

Help people... This is a mini platform game. All is nice and working except when I tried to add a…
 Amber ChenMay 10 at 1:02 AM
Amber ChenMay 10 at 1:02 AM
Update: Parameters week sketch using noise and a for loop for movement.
 Gabriel MesterMay 9 at 8:35 PM
Gabriel MesterMay 9 at 8:35 PM


Find the odd one out in the panda pile :) || Second one is a still for you all to try || Third on…
 Amber ChenMay 8 at 11:37 PM
Amber ChenMay 8 at 11:37 PM
dont catch any bad vibes!
 Talia CottonMay 8 at 4:35 AM
Talia CottonMay 8 at 4:35 AM
catch the mouse and win. spacebar controls trap, as well as refresh.
 Talia CottonMay 8 at 3:30 AM
Talia CottonMay 8 at 3:30 AM
A little sunshine to everyone's day
 Talia CottonMay 5 at 7:23 PM
Talia CottonMay 5 at 7:23 PM
Learning how to subdivide a surface in Houdini.
 Enayet KabirMay 5 at 7:06 PM
Enayet KabirMay 5 at 7:06 PM
Learning about applying UV maps to geometry in Houdini.
 Enayet KabirMay 5 at 7:05 PM
Enayet KabirMay 5 at 7:05 PM
More experiments with applying random values to variables in Houdini.
 Enayet KabirMay 5 at 7:05 PM
Enayet KabirMay 5 at 7:05 PM
Learning about applying random values to variables in Houdini.
 Enayet KabirMay 5 at 7:04 PM
Enayet KabirMay 5 at 7:04 PM
Learning about distributing points along a grid in Houdini
 Enayet KabirMay 5 at 7:04 PM
Enayet KabirMay 5 at 7:04 PM
Learning about vertex manipulation in Houdini
 Enayet KabirMay 5 at 7:03 PM
Enayet KabirMay 5 at 7:03 PM


My first 3D print.
 Kim KoehlerMay 5 at 6:43 PM
Kim KoehlerMay 5 at 6:43 PM


Class challange.
 Kim KoehlerMay 5 at 6:31 PM
Kim KoehlerMay 5 at 6:31 PM

 Danielle SobelMay 5 at 5:44 PM
Danielle SobelMay 5 at 5:44 PM
Pipes into a ring. :)
 Danielle SobelMay 5 at 4:52 PM
Danielle SobelMay 5 at 4:52 PM
// last one //
 S. I.May 5 at 4:47 PM
S. I.May 5 at 4:47 PM
3D print
 Jennifer LeeMay 5 at 4:40 PM
Jennifer LeeMay 5 at 4:40 PM


Making Pipes: I used union() for the upper and lower arm and difference() to make the bends
 Danielle SobelMay 5 at 4:30 PM
Danielle SobelMay 5 at 4:30 PM


 Jennifer LeeMay 5 at 4:00 PM
Jennifer LeeMay 5 at 4:00 PM


Groovy DiscoMan
 Jennifer LeeMay 5 at 10:00 AM
Jennifer LeeMay 5 at 10:00 AM
OK SO THIS IS ACTUALLY SUPER EXCITING FOR ME
 S. I.May 5 at 5:56 AM
S. I.May 5 at 5:56 AM
Update Parametric: never posted sketch used for my (unprinted) cherry blossom poster.
 Gabriel MesterMay 5 at 2:00 AM
Gabriel MesterMay 5 at 2:00 AM


// kind of having lots of fun with this //
 S. I.May 5 at 1:33 AM
S. I.May 5 at 1:33 AM

 S. I.May 5 at 1:19 AM
S. I.May 5 at 1:19 AM
Update Week11: Working on integrating this to my website for more interactive fun with my drawing…
 Gabriel MesterMay 5 at 1:19 AM
Gabriel MesterMay 5 at 1:19 AM


Actually really useful: 45RPM records adaptor that-always-gets-lost, at the right scale. Will pro…
 Gabriel MesterMay 5 at 1:13 AM
Gabriel MesterMay 5 at 1:13 AM

How I react when someone asks me what my plans are after graduation....
 Sachi ChandiramaniMay 5 at 12:00 AM
Sachi ChandiramaniMay 5 at 12:00 AM
Bring your records (Technics MK2 replica)
 Gabriel MesterMay 4 at 11:09 PM
Gabriel MesterMay 4 at 11:09 PM


Stamps adjustable with a variable for my Thesis1 final presentation.
 Gabriel MesterMay 4 at 11:06 PM
Gabriel MesterMay 4 at 11:06 PM


Class challenges
 Gabriel MesterMay 4 at 10:54 PM
Gabriel MesterMay 4 at 10:54 PM

why is it doing this ????????? ????? ? ?
 S. I.May 4 at 10:54 PM
S. I.May 4 at 10:54 PM
// on my way to understanding the basics //
 S. I.May 4 at 10:44 PM
S. I.May 4 at 10:44 PM

Own name in a negative Chinese seal
 Jonathan KhoMay 4 at 9:14 PM
Jonathan KhoMay 4 at 9:14 PM

The object I tried to replicate is called "玉璽", which translates to "seal". <…
 Jonathan KhoMay 4 at 8:06 PM
Jonathan KhoMay 4 at 8:06 PM
the screen saver aesthetics
 Amber ChenMay 4 at 7:54 PM
Amber ChenMay 4 at 7:54 PM


 Sachi ChandiramaniMay 4 at 7:43 PM
Sachi ChandiramaniMay 4 at 7:43 PM
Spinning DNA strand
 Jonathan KhoMay 4 at 7:02 PM
Jonathan KhoMay 4 at 7:02 PM


 Bateel SaberMay 4 at 4:09 PM
Bateel SaberMay 4 at 4:09 PM
Hello World, I need to be cleaned up a bit....
 Sachi ChandiramaniMay 4 at 2:33 PM
Sachi ChandiramaniMay 4 at 2:33 PM

 Bateel SaberMay 4 at 4:35 AM
Bateel SaberMay 4 at 4:35 AM

Type poster time. The second is the top view of the model.
 Amber ChenMay 4 at 4:35 AM
Amber ChenMay 4 at 4:35 AM


Made with text no. 2
 Dorothy CruzMay 4 at 2:45 AM
Dorothy CruzMay 4 at 2:45 AM


Made with text no. 1
 Dorothy CruzMay 4 at 2:27 AM
Dorothy CruzMay 4 at 2:27 AM
// weird thing //
 S. I.May 3 at 10:39 PM
S. I.May 3 at 10:39 PM

// playing with extruding shapes //
 S. I.May 3 at 9:39 PM
S. I.May 3 at 9:39 PM
Going to go print my snowman! Had trouble with the arms, but otherwise had fun! (Dorothy, if you…
 Sachi ChandiramaniMay 3 at 5:13 PM
Sachi ChandiramaniMay 3 at 5:13 PM
 Bateel SaberMay 3 at 5:01 PM
Bateel SaberMay 3 at 5:01 PM

Okay, I got a just a tad ahead of myself..... Saw this on thingiverse and wanted to attempt. LOL…
 Sachi ChandiramaniMay 3 at 5:58 AM
Sachi ChandiramaniMay 3 at 5:58 AM
Completed 3D model. Hope it'll print well. There's definitely no place it could possibly…
 Amber ChenMay 3 at 4:16 AM
Amber ChenMay 3 at 4:16 AM


Printed. It is hard to clean edges.
 Jane LeeMay 3 at 1:48 AM
Jane LeeMay 3 at 1:48 AM


Just printed these miniatures! I'll be taking more pictures of it.
 Dorothy CruzMay 2 at 4:56 PM
Dorothy CruzMay 2 at 4:56 PM

 Danielle SobelMay 2 at 4:23 PM
Danielle SobelMay 2 at 4:23 PM

 Danielle SobelMay 2 at 4:20 PM
Danielle SobelMay 2 at 4:20 PM

So my parents birthdays are coming up really soon and I thought that maybe I should make somethin…
 Amber ChenMay 2 at 2:47 PM
Amber ChenMay 2 at 2:47 PM


Closer look of Nome
 Jane LeeMay 2 at 6:32 AM
Jane LeeMay 2 at 6:32 AM


Nome from Little nightmares game. The game is short but amazingggg!!
 Jane LeeMay 2 at 6:27 AM
Jane LeeMay 2 at 6:27 AM

I feel like printing this too. I don't quite count this as a sketch. Next, I will try explori…
 Dorothy CruzMay 2 at 3:19 AM
Dorothy CruzMay 2 at 3:19 AM
 Bateel SaberMay 2 at 1:42 AM
Bateel SaberMay 2 at 1:42 AM


Final version of the robot! (Gave up on the hand) I will be printing this tomorrow. EDIT: Did the…
 Dorothy CruzMay 1 at 11:06 PM
Dorothy CruzMay 1 at 11:06 PM
 Bateel SaberMay 1 at 5:36 PM
Bateel SaberMay 1 at 5:36 PM


Recreated an old drawing from 2014 of a robot. This is part #1. I'll keep working on it. I mi…
 Dorothy CruzMay 1 at 4:58 AM
Dorothy CruzMay 1 at 4:58 AM
Used rotate_extrude to get this donut shape.
 Jennifer LeeMay 1 at 3:13 AM
Jennifer LeeMay 1 at 3:13 AM


Final rendered object
 Jennifer LeeMay 1 at 1:46 AM
Jennifer LeeMay 1 at 1:46 AM

In-progress
 Jennifer LeeMay 1 at 1:44 AM
Jennifer LeeMay 1 at 1:44 AM

// sound week // instrument //
 S. I.May 1 at 1:29 AM
S. I.May 1 at 1:29 AM
From CF Strategies week. Balls decrease in size as a force from the collision.
 Kim KoehlerApril 30 at 6:55 PM
Kim KoehlerApril 30 at 6:55 PM
Also from noise week.
 Kim KoehlerApril 30 at 6:53 PM
Kim KoehlerApril 30 at 6:53 PM
From noise week.
 Kim KoehlerApril 30 at 6:51 PM
Kim KoehlerApril 30 at 6:51 PM
Turn down your volume!
 Kim KoehlerApril 30 at 6:36 PM
Kim KoehlerApril 30 at 6:36 PM

Screenshot of something made during class yesterday
 Amber ChenApril 30 at 12:26 AM
Amber ChenApril 30 at 12:26 AM
!!!!DECREASE YOU VOLUME!!!!
 Kim KoehlerApril 29 at 10:45 PM
Kim KoehlerApril 29 at 10:45 PM


I've been watching Digimon Adventure Tri, so I decided to make a Digivice. openScad is so muc…
 Dorothy CruzApril 29 at 6:53 PM
Dorothy CruzApril 29 at 6:53 PM


A lamp that I made yesterday in class.
 Dorothy CruzApril 29 at 6:51 PM
Dorothy CruzApril 29 at 6:51 PM

Generating a "ward" keychain. For those of you play League of Legends
 Jonathan KhoApril 28 at 11:02 PM
Jonathan KhoApril 28 at 11:02 PM
the keyboard & its functions
 Talia CottonApril 28 at 7:40 PM
Talia CottonApril 28 at 7:40 PM
Can't manage to export or screen capture with the sound and soundflower, so here's a scre…
 Gabriel MesterApril 28 at 7:32 PM
Gabriel MesterApril 28 at 7:32 PM

Some explanatory videos on my progress on the development of the keyboard's functions.
 Talia CottonApril 28 at 7:23 PM
Talia CottonApril 28 at 7:23 PM
 Kim KoehlerApril 28 at 7:21 PM
Kim KoehlerApril 28 at 7:21 PM



From last week
 Kim KoehlerApril 28 at 7:11 PM
Kim KoehlerApril 28 at 7:11 PM
From last week
 Kim KoehlerApril 28 at 7:09 PM
Kim KoehlerApril 28 at 7:09 PM
The soundscape from the last piece has been layered over with two more layers. Firstly a layer of…
 Enayet KabirApril 28 at 6:52 PM
Enayet KabirApril 28 at 6:52 PM
Granular soundscape made from multiple recordings I took in Dhaka city. The granular synthesizer…
 Enayet KabirApril 28 at 6:50 PM
Enayet KabirApril 28 at 6:50 PM
Something I'm working on. The pitch and stereo position of each hit of the clicky percussion…
 Enayet KabirApril 28 at 6:48 PM
Enayet KabirApril 28 at 6:48 PM
Probability based percussion (only the 4x4 kick pattern is hard programmed)
 Enayet KabirApril 28 at 6:47 PM
Enayet KabirApril 28 at 6:47 PM
Randomized legato switching breaks
 Enayet KabirApril 28 at 6:47 PM
Enayet KabirApril 28 at 6:47 PM
Randomized arpeggiator
 Enayet KabirApril 28 at 6:46 PM
Enayet KabirApril 28 at 6:46 PM
Used two oscillator files into the loop example to create a different sound
 Jennifer LeeApril 28 at 6:11 PM
Jennifer LeeApril 28 at 6:11 PM
 Jennifer LeeApril 28 at 6:10 PM
Jennifer LeeApril 28 at 6:10 PM
 Jennifer LeeApril 28 at 6:09 PM
Jennifer LeeApril 28 at 6:09 PM
loop example
 Jennifer LeeApril 28 at 4:35 PM
Jennifer LeeApril 28 at 4:35 PM
Oscillator Frequency example
 Jennifer LeeApril 28 at 4:13 PM
Jennifer LeeApril 28 at 4:13 PM
Rect and FFT
 Danielle SobelApril 28 at 3:03 PM
Danielle SobelApril 28 at 3:03 PM


FFT- Three Tests with Lines. https://p5js.org/refer…
 Danielle SobelApril 28 at 2:39 PM
Danielle SobelApril 28 at 2:39 PM
Sound Effects with mousePressed() Pig, a dog barking, and a door closing
 Danielle SobelApril 28 at 1:55 PM
Danielle SobelApril 28 at 1:55 PM
 Jane LeeApril 28 at 7:38 AM
Jane LeeApril 28 at 7:38 AM
 Jane LeeApril 28 at 7:18 AM
Jane LeeApril 28 at 7:18 AM
 Jane LeeApril 28 at 6:49 AM
Jane LeeApril 28 at 6:49 AM
 Jane LeeApril 28 at 6:34 AM
Jane LeeApril 28 at 6:34 AM
How I feel about electric guitar playing
Image Link:
 Jane LeeApril 28 at 6:12 AM
Jane LeeApril 28 at 6:12 AM
Amplitude Analysis - Figuring out volume of a song.
 Danielle SobelApril 28 at 5:41 AM
Danielle SobelApril 28 at 5:41 AM
Balls Sync.
 Jonathan KhoApril 28 at 1:11 AM
Jonathan KhoApril 28 at 1:11 AM
Helium machine : )
 Amber ChenApril 28 at 1:10 AM
Amber ChenApril 28 at 1:10 AM
Been trying to use mic input, and I really think it's working, however everytime I try and gr…
 Sachi ChandiramaniApril 27 at 11:44 PM
Sachi ChandiramaniApril 27 at 11:44 PM

 Bateel SaberApril 27 at 11:33 PM
Bateel SaberApril 27 at 11:33 PM
Looping Kim with rate()
 Jonathan KhoApril 27 at 11:32 PM
Jonathan KhoApril 27 at 11:32 PM
 Bateel SaberApril 27 at 10:12 PM
Bateel SaberApril 27 at 10:12 PM


TNS Library
 Bateel SaberApril 27 at 9:43 PM
Bateel SaberApril 27 at 9:43 PM
Trump most of the time ;)
Decided to use the sliders from Parameters to toggle the "m…
 Jonathan KhoApril 27 at 9:08 PM
Jonathan KhoApril 27 at 9:08 PM

Our President 😱
The graphic are ellipses from the sound clips that formed together and go…
 Sachi ChandiramaniApril 27 at 8:43 PM
Sachi ChandiramaniApril 27 at 8:43 PM
 Bateel SaberApril 27 at 8:37 PM
Bateel SaberApril 27 at 8:37 PM
Wait till the end.
 Dorothy CruzApril 27 at 8:26 PM
Dorothy CruzApril 27 at 8:26 PM
The closer my face, the louder it screams.
 Jonathan KhoApril 27 at 8:23 PM
Jonathan KhoApril 27 at 8:23 PM

Took a little while to get this to record the sound. But here it is. You're supposed to be ab…
 Sachi ChandiramaniApril 27 at 7:52 PM
Sachi ChandiramaniApril 27 at 7:52 PM
 Bateel SaberApril 27 at 7:40 PM
Bateel SaberApril 27 at 7:40 PM

One with colors that change with freq, the other testing out the 3D animation. The animation does…
 Jonathan KhoApril 27 at 6:34 PM
Jonathan KhoApril 27 at 6:34 PM


The length of the lines and of the the color are affected by the volume of the audio, and the inp…
 Dorothy CruzApril 27 at 3:16 PM
Dorothy CruzApril 27 at 3:16 PM
music played going faster every interval
 Amber ChenApril 27 at 2:10 PM
Amber ChenApril 27 at 2:10 PM


My output doesn't come out right. Here are 3 trials. I am playing the some around 12 times m…
 Dorothy CruzApril 27 at 4:29 AM
Dorothy CruzApril 27 at 4:29 AM
Slider Rate & Slider Pan : Really trying to learn how to do this. Starting from loading sound…
 Danielle SobelApril 27 at 4:16 AM
Danielle SobelApril 27 at 4:16 AM


The audio might be a little bit off.
 Dorothy CruzApril 27 at 3:13 AM
Dorothy CruzApril 27 at 3:13 AM
Color changes base on the volume, but that value is also randomize. This is the audio I used: Shi…
 Dorothy CruzApril 26 at 11:40 PM
Dorothy CruzApril 26 at 11:40 PM
Rock Paper Scissors || Quality content with generated sounds. I forgot what I was going to put do…
 Amber ChenApril 26 at 3:43 AM
Amber ChenApril 26 at 3:43 AM
This is very simple because it took me a while to play around with code and play with p5 examples…
 Sachi ChandiramaniApril 26 at 2:45 AM
Sachi ChandiramaniApril 26 at 2:45 AM
 Enayet KabirApril 25 at 2:27 AM
Enayet KabirApril 25 at 2:27 AM
 Enayet KabirApril 25 at 2:26 AM
Enayet KabirApril 25 at 2:26 AM
 Enayet KabirApril 25 at 2:26 AM
Enayet KabirApril 25 at 2:26 AM
 Enayet KabirApril 25 at 2:26 AM
Enayet KabirApril 25 at 2:26 AM
 Enayet KabirApril 25 at 2:25 AM
Enayet KabirApril 25 at 2:25 AM
***UPDATE: *** Some tips for those who are just starting their sketch. || After Justin's sugg…
 Amber ChenApril 25 at 2:24 AM
Amber ChenApril 25 at 2:24 AM
texchur
 Enayet KabirApril 25 at 2:19 AM
Enayet KabirApril 25 at 2:19 AM
Random Friend Guy
 Enayet KabirApril 25 at 1:56 AM
Enayet KabirApril 25 at 1:56 AM
glitch type drawing tool
 Enayet KabirApril 25 at 1:55 AM
Enayet KabirApril 25 at 1:55 AM

WARNING: CRACKING SOUNDS DUE TO EXPORT ISSUES Oscillator played by keyboard butt…
 Amber ChenApril 24 at 10:50 PM
Amber ChenApril 24 at 10:50 PM
tetris.
 Talia CottonApril 23 at 3:22 AM
Talia CottonApril 23 at 3:22 AM
// simple oscillator + modulator // press space = modulator on //
 S. I.April 23 at 3:15 AM
S. I.April 23 at 3:15 AM


Part 2:
Added functionality to play more than one note at the same time. (vids 1, 2, 3);…
 Talia CottonApril 23 at 1:52 AM
Talia CottonApril 23 at 1:52 AM
Part 1. Getting it to play.
Issues: Not sure why the buzzing sound is there. It gets…
 Talia CottonApril 22 at 9:42 PM
Talia CottonApril 22 at 9:42 PM
Startup Pitch Generator
 Enayet KabirApril 21 at 8:03 PM
Enayet KabirApril 21 at 8:03 PM
Dance Music Sub Genre Generator
 Enayet KabirApril 21 at 8:03 PM
Enayet KabirApril 21 at 8:03 PM
Type elevator with jQuery
 Gabriel MesterApril 21 at 7:47 PM
Gabriel MesterApril 21 at 7:47 PM
 Bateel SaberApril 21 at 7:41 PM
Bateel SaberApril 21 at 7:41 PM
PopUps with JavaScript generates a sentence. I figured out how to do this here:
 Danielle SobelApril 21 at 7:19 PM
Danielle SobelApril 21 at 7:19 PM
Randomly styled references.
 Gabriel MesterApril 21 at 7:15 PM
Gabriel MesterApril 21 at 7:15 PM


 Dorothy CruzApril 21 at 7:07 PM
Dorothy CruzApril 21 at 7:07 PM
Footwork (dance music style from Chicago), lyric generator.
This is based on a sample set…
 Enayet KabirApril 21 at 7:07 PM
Enayet KabirApril 21 at 7:07 PM
OkCupid username generator
 Enayet KabirApril 21 at 7:06 PM
Enayet KabirApril 21 at 7:06 PM


Weed strain name generator
 Enayet KabirApril 21 at 7:05 PM
Enayet KabirApril 21 at 7:05 PM
Rainy Days are Like.
 Danielle SobelApril 21 at 5:39 PM
Danielle SobelApril 21 at 5:39 PM

 Sachi ChandiramaniApril 21 at 5:39 PM
Sachi ChandiramaniApril 21 at 5:39 PM


Inspired by Charles M. Shultz's comics 'Dark and Stormy Night.'
 Danielle SobelApril 21 at 3:38 PM
Danielle SobelApril 21 at 3:38 PM


DT inspiration. Thought about generating text for a kindle :). Vecteezy graphic:
 Danielle SobelApril 21 at 2:53 PM
Danielle SobelApril 21 at 2:53 PM
 Jane LeeApril 21 at 10:14 AM
Jane LeeApril 21 at 10:14 AM

Mary Oliver's Wild Geese
 Jane LeeApril 21 at 9:32 AM
Jane LeeApril 21 at 9:32 AM
LG slogan
 Jane LeeApril 21 at 9:04 AM
Jane LeeApril 21 at 9:04 AM

Inspired by a poster from thebeaststudio
 Jane LeeApril 21 at 8:47 AM
Jane LeeApril 21 at 8:47 AM
 Jane LeeApril 21 at 8:09 AM
Jane LeeApril 21 at 8:09 AM
// slot machine extended // runs when holding down space //
 S. I.April 21 at 6:06 AM
S. I.April 21 at 6:06 AM
Might need to go to bed.
 Gabriel MesterApril 21 at 5:21 AM
Gabriel MesterApril 21 at 5:21 AM

Complete chapter one. Generate your own at bit.ly/talia-dark-stormy
 Talia CottonApril 21 at 5:02 AM
Talia CottonApril 21 at 5:02 AM


Mad Libs
 Jennifer LeeApril 21 at 4:03 AM
Jennifer LeeApril 21 at 4:03 AM


- Espresso 2) 蜜柑Mikan (Citrus unshiu) 3) Take your guess! || Yes it's a riddle generator.…
 Amber ChenApril 21 at 3:59 AM
Amber ChenApril 21 at 3:59 AM
Drafting a webpage for Thesis1 using jQuery for image interactivity.
 Gabriel MesterApril 21 at 3:46 AM
Gabriel MesterApril 21 at 3:46 AM
Some pub names from my story. Sorry for the thumbnail frame...
 Talia CottonApril 21 at 3:40 AM
Talia CottonApril 21 at 3:40 AM
Ran out of ideas so I went for a shower and suddenly the scene where Justin was talking about Gei…
 Jonathan KhoApril 21 at 3:31 AM
Jonathan KhoApril 21 at 3:31 AM
The Hobbit Synopsis (reimagined)
 Jennifer LeeApril 21 at 3:28 AM
Jennifer LeeApril 21 at 3:28 AM

// searching for a keyword on twitter + displaying the tweets on a webpage // using python + js +…
 S. I.April 21 at 3:12 AM
S. I.April 21 at 3:12 AM


It is pretty common in DR to name your kids with a combination of both mother and father's na…
 Dorothy CruzApril 21 at 2:44 AM
Dorothy CruzApril 21 at 2:44 AM
This was supposed to be a scary story that would type out the letters one by one. I couldn't…
 Sachi ChandiramaniApril 21 at 2:11 AM
Sachi ChandiramaniApril 21 at 2:11 AM
PLAY AUDIO!
Bateel I did it !!!
 Jonathan KhoApril 21 at 2:07 AM
Jonathan KhoApril 21 at 2:07 AM


Agh, attempted alliteration generator. User inputs text (must be long, hah) and the program finds…
 Talia CottonApril 21 at 2:03 AM
Talia CottonApril 21 at 2:03 AM
// word slot machine // building on last sketch // holding down + releasing the space bar // (lov…
 S. I.April 21 at 1:37 AM
S. I.April 21 at 1:37 AM


In class we were given many methods for generating text: Markov chains, the Underscore library, e…
 Talia CottonApril 20 at 11:59 PM
Talia CottonApril 20 at 11:59 PM


Chapter one page of the fantasy adventures of Comp Form class members.
 Amber ChenApril 20 at 11:30 PM
Amber ChenApril 20 at 11:30 PM
Inspired by Bateel's KFC ad's. Tried one with Nike! (Also, oops, at the words).
 Sachi ChandiramaniApril 20 at 11:23 PM
Sachi ChandiramaniApril 20 at 11:23 PM

All the rumors are true, I love squirrels.
 Sachi ChandiramaniApril 20 at 11:22 PM
Sachi ChandiramaniApril 20 at 11:22 PM
Trying to make it as creepy as possible.
Played around with mix-blend-mode and animations…
 Jonathan KhoApril 20 at 10:35 PM
Jonathan KhoApril 20 at 10:35 PM
Goal: to make a t-shirt saying maker. I think to make it look more finished I can work on making…
 Danielle SobelApril 20 at 9:50 PM
Danielle SobelApril 20 at 9:50 PM
(look at that alliteration!)
 Talia CottonApril 20 at 7:11 PM
Talia CottonApril 20 at 7:11 PM
 Bateel SaberApril 20 at 6:36 PM
Bateel SaberApril 20 at 6:36 PM
Using Markov chain with Dr. Seuss stories
 Jennifer LeeApril 20 at 6:00 AM
Jennifer LeeApril 20 at 6:00 AM
Picket sign generator
 Gabriel MesterApril 20 at 5:14 AM
Gabriel MesterApril 20 at 5:14 AM
 Bateel SaberApril 20 at 4:56 AM
Bateel SaberApril 20 at 4:56 AM

A few little code hints I had to figure out that you might find helpful!
1.
 Talia CottonApril 20 at 4:38 AM
Talia CottonApril 20 at 4:38 AM
 Jennifer LeeApril 20 at 4:19 AM
Jennifer LeeApril 20 at 4:19 AM
 Jennifer LeeApril 20 at 4:10 AM
Jennifer LeeApril 20 at 4:10 AM

Trump and Putin having a talk about national security on fb. || Generated with the Markov Chain.…
 Amber ChenApril 20 at 4:03 AM
Amber ChenApril 20 at 4:03 AM


Stay tuned to find out what happens to Katie, Ralph and Chris. // worked on perfecting the…
 Talia CottonApril 20 at 3:41 AM
Talia CottonApril 20 at 3:41 AM


Card Against Humanity. I took two phrases from the bunch and each is been filled in the blank wit…
 Dorothy CruzApril 20 at 2:34 AM
Dorothy CruzApril 20 at 2:34 AM
 Bateel SaberApril 20 at 2:11 AM
Bateel SaberApril 20 at 2:11 AM

I got way too ahead of myself. I wanted to make a generator that would read the first letter of y…
 Sachi ChandiramaniApril 20 at 1:27 AM
Sachi ChandiramaniApril 20 at 1:27 AM

Inspired by the online images of failed tattoos non-Chinese people make :D
Translation on…
 Jonathan KhoApril 20 at 12:21 AM
Jonathan KhoApril 20 at 12:21 AM
"The quick brown fox jumps over the lazy dog"
Pages auto refreshes every 1 secon…
 Jonathan KhoApril 19 at 10:44 PM
Jonathan KhoApril 19 at 10:44 PM


How stereotypical is this? 😅 Metal band generator.
 Dorothy CruzApril 19 at 10:26 PM
Dorothy CruzApril 19 at 10:26 PM


 Bateel SaberApril 19 at 9:46 PM
Bateel SaberApril 19 at 9:46 PM


// typeface: euclid flex medium + awful kerning sorry //
 S. I.April 19 at 9:06 PM
S. I.April 19 at 9:06 PM


Haiku Generator 2.0 || Worked in with some of the points I mentioned from the last post. More wor…
 Amber ChenApril 19 at 4:09 AM
Amber ChenApril 19 at 4:09 AM


 Kim KoehlerApril 19 at 2:20 AM
Kim KoehlerApril 19 at 2:20 AM

Didnt work out the way I wanted. Not sure if paper.js is not made for exporting animations, but:<…
 Kim KoehlerApril 19 at 2:16 AM
Kim KoehlerApril 19 at 2:16 AM
 Kim KoehlerApril 19 at 2:16 AM
Kim KoehlerApril 19 at 2:16 AM


 Kim KoehlerApril 19 at 2:14 AM
Kim KoehlerApril 19 at 2:14 AM


The weekly challange
 Kim KoehlerApril 19 at 2:13 AM
Kim KoehlerApril 19 at 2:13 AM
// ahhh sorry for the typo -- THIS* not THIE // generative sale bot //
 S. I.April 17 at 5:31 PM
S. I.April 17 at 5:31 PM

Haiku generator... Writing poems never came this easy back in English class . Haiku generally fol…
 Amber ChenApril 17 at 4:29 AM
Amber ChenApril 17 at 4:29 AM
 Enayet KabirApril 14 at 8:02 PM
Enayet KabirApril 14 at 8:02 PM
 Enayet KabirApril 14 at 8:01 PM
Enayet KabirApril 14 at 8:01 PM
 Enayet KabirApril 14 at 7:49 PM
Enayet KabirApril 14 at 7:49 PM
Parallax type effect
 Enayet KabirApril 14 at 7:49 PM
Enayet KabirApril 14 at 7:49 PM
 Enayet KabirApril 14 at 7:47 PM
Enayet KabirApril 14 at 7:47 PM
Decagon Animation: Using an on frame event and the rotate function.
 Danielle SobelApril 14 at 7:12 PM
Danielle SobelApril 14 at 7:12 PM


// poster // the last image is a screenshot of initial sketch - so the hardest part was that the…
 S. I.April 14 at 6:46 PM
S. I.April 14 at 6:46 PM
Trying to work on my graphic design skills :) This is my first poster I've ever made and it l…
 Danielle SobelApril 14 at 6:18 PM
Danielle SobelApril 14 at 6:18 PM

Laser cutting!! :D I will take the final piece to the class.
 Dorothy CruzApril 14 at 5:29 PM
Dorothy CruzApril 14 at 5:29 PM
This took forever to figure out :/ Goal was to create a sketch to move multiple shapes around. I…
 Danielle SobelApril 14 at 3:05 PM
Danielle SobelApril 14 at 3:05 PM

Some play. I think I was getting caught up in mathy thinking too much this week, so I wanted a ba…
 Talia CottonApril 14 at 5:05 AM
Talia CottonApril 14 at 5:05 AM


¯_(ツ)_/¯ When laser cut is no longer an option. I started with the whole beverage graphic and had…
 Amber ChenApril 14 at 4:56 AM
Amber ChenApril 14 at 4:56 AM
Thought I'd post the original inspiration behind the whole laser cut project. This was the st…
 Talia CottonApril 14 at 4:33 AM
Talia CottonApril 14 at 4:33 AM

 Talia CottonApril 14 at 4:25 AM
Talia CottonApril 14 at 4:25 AM

I will try to laser cut this tomorrow. 🙃 A bit late ik. READY.
 Dorothy CruzApril 14 at 2:05 AM
Dorothy CruzApril 14 at 2:05 AM

Thesis-related content abstractification examples. Trying to work on a similar concept digitally.…
 Gabriel MesterApril 14 at 1:08 AM
Gabriel MesterApril 14 at 1:08 AM
 Bateel SaberApril 14 at 12:21 AM
Bateel SaberApril 14 at 12:21 AM
An exhibition poster for Yayoi Kasuma.
 Sachi ChandiramaniApril 14 at 12:07 AM
Sachi ChandiramaniApril 14 at 12:07 AM
 Jennifer LeeApril 13 at 11:02 PM
Jennifer LeeApril 13 at 11:02 PM
 Jennifer LeeApril 13 at 10:51 PM
Jennifer LeeApril 13 at 10:51 PM


Having too much fun with this! Help from:
 Sachi ChandiramaniApril 13 at 10:07 PM
Sachi ChandiramaniApril 13 at 10:07 PM
I've been struggling with this one, I tried to have the text come up on mouse click. And I tr…
 Sachi ChandiramaniApril 13 at 8:46 PM
Sachi ChandiramaniApril 13 at 8:46 PM
Been obsessed with blend mode and hue change!
 Sachi ChandiramaniApril 13 at 8:43 PM
Sachi ChandiramaniApril 13 at 8:43 PM


I tried so hard and got so far, but in the end it doesn't even matter because getting the old…
 Amber ChenApril 13 at 6:29 PM
Amber ChenApril 13 at 6:29 PM
 Danielle SobelApril 13 at 1:58 PM
Danielle SobelApril 13 at 1:58 PM
it...... it works.
 Talia CottonApril 13 at 3:52 AM
Talia CottonApril 13 at 3:52 AM


Decided to have fun with Illustrator instead. 😅😅😅😅 I don't want to do this anymore. 🙃
 Dorothy CruzApril 13 at 3:10 AM
Dorothy CruzApril 13 at 3:10 AM
 Bateel SaberApril 13 at 1:36 AM
Bateel SaberApril 13 at 1:36 AM


VERY ready for failure and psyched about it. Laser cut sketches, next step code.
 Talia CottonApril 12 at 10:56 PM
Talia CottonApril 12 at 10:56 PM
whattttttttttttttttttwhyyyyyyyy
 S. I.April 12 at 10:35 PM
S. I.April 12 at 10:35 PM
 Bateel SaberApril 12 at 6:07 PM
Bateel SaberApril 12 at 6:07 PM


These are the sketches of the sketch for the sort of challenge. Started on paper to have a clear…
 Dorothy CruzApril 12 at 5:46 PM
Dorothy CruzApril 12 at 5:46 PM


Wanted to round the edges, but apparently it only works for the rectangles. Tho I really love thi…
 Dorothy CruzApril 12 at 2:30 AM
Dorothy CruzApril 12 at 2:30 AM
Obsessed
 Bateel SaberApril 11 at 8:47 PM
Bateel SaberApril 11 at 8:47 PM
little monster
 S. I.April 11 at 7:40 PM
S. I.April 11 at 7:40 PM


Trying to work with pixels. Photo source:
 Dorothy CruzApril 11 at 6:16 PM
Dorothy CruzApril 11 at 6:16 PM


Party Time! Made a random confetti generator. Some fun play with bezier curves and handles (see…
 Talia CottonApril 11 at 4:18 PM
Talia CottonApril 11 at 4:18 PM


Wanted to draw something too! It is Hanami season. Every time you press the return key the color…
 Dorothy CruzApril 11 at 3:42 PM
Dorothy CruzApril 11 at 3:42 PM
 Bateel SaberApril 11 at 3:19 AM
Bateel SaberApril 11 at 3:19 AM
// learning //
 S. I.April 10 at 11:24 PM
S. I.April 10 at 11:24 PM

more with sine waves // in sketch 1 each wave has a different frequency + using the selected = tr…
 S. I.April 10 at 5:19 AM
S. I.April 10 at 5:19 AM

//whatever this is it took longer than it should have//
 S. I.April 10 at 2:53 AM
S. I.April 10 at 2:53 AM

Vector drawing tool! Randomized color each stroke and has a random scribble effect. The second im…
 Amber ChenApril 10 at 2:18 AM
Amber ChenApril 10 at 2:18 AM

I see people making cool looking spirograph-like graphics from the turtle the other day with pape…
 Amber ChenApril 10 at 2:15 AM
Amber ChenApril 10 at 2:15 AM


Some circle fun! With help from:
 Sachi ChandiramaniApril 10 at 12:37 AM
Sachi ChandiramaniApril 10 at 12:37 AM
Face that changes emotion and size based on user input. All the shapes are based off of the initi…
 Talia CottonApril 9 at 5:25 PM
Talia CottonApril 9 at 5:25 PM

The Challenge... Also tried using events to make it move
SPOILER CODE ALERT!
// Cre…
 Jonathan KhoApril 8 at 8:40 PM
Jonathan KhoApril 8 at 8:40 PM

Collection of randomly generated graphics. First one uses smooth({type:asymmetric}); while the se…
 Amber ChenApril 8 at 7:26 PM
Amber ChenApril 8 at 7:26 PM
 Jane LeeApril 7 at 7:50 PM
Jane LeeApril 7 at 7:50 PM
 Gabriel MesterApril 7 at 7:44 PM
Gabriel MesterApril 7 at 7:44 PM
 Kim KoehlerApril 7 at 7:27 PM
Kim KoehlerApril 7 at 7:27 PM
 Kim KoehlerApril 7 at 7:26 PM
Kim KoehlerApril 7 at 7:26 PM
 Kim KoehlerApril 7 at 7:25 PM
Kim KoehlerApril 7 at 7:25 PM

More tutorials and exploring
 Kim KoehlerApril 7 at 7:24 PM
Kim KoehlerApril 7 at 7:24 PM


Getting started, reading up on Vuo..
 Kim KoehlerApril 7 at 7:23 PM
Kim KoehlerApril 7 at 7:23 PM
This is also from Turtle week. And this one I got running after som trouble shooting, yayy!
 Kim KoehlerApril 7 at 7:18 PM
Kim KoehlerApril 7 at 7:18 PM
Same here, the more advanced versions I still cant get to run.
 Kim KoehlerApril 7 at 7:17 PM
Kim KoehlerApril 7 at 7:17 PM
Lol, sketch from last week(turtles) that I still dont get to work after another week of troublesh…
 Kim KoehlerApril 7 at 7:16 PM
Kim KoehlerApril 7 at 7:16 PM
 Bateel SaberApril 7 at 6:02 PM
Bateel SaberApril 7 at 6:02 PM
stereoscopic // patch help from max neuport
 S. I.April 7 at 5:38 PM
S. I.April 7 at 5:38 PM
 S. I.April 7 at 5:35 PM
S. I.April 7 at 5:35 PM
 Bateel SaberApril 7 at 3:34 PM
Bateel SaberApril 7 at 3:34 PM
Using gradient noise Bee Image:
 Danielle SobelApril 7 at 3:31 PM
Danielle SobelApril 7 at 3:31 PM

Counting up in the console
 Danielle SobelApril 7 at 2:07 PM
Danielle SobelApril 7 at 2:07 PM
Puppy Rotation
 Danielle SobelApril 7 at 1:39 PM
Danielle SobelApril 7 at 1:39 PM

Counting
 Danielle SobelApril 7 at 12:50 PM
Danielle SobelApril 7 at 12:50 PM

Puppy (adding an image file) & Hello World (Text)
 Danielle SobelApril 7 at 12:22 PM
Danielle SobelApril 7 at 12:22 PM
Still learning
 Danielle SobelApril 7 at 11:58 AM
Danielle SobelApril 7 at 11:58 AM
Was attempting to get the sphere to twirl. I tried using "show back of 3D object, but I'…
 Sachi ChandiramaniApril 7 at 10:54 AM
Sachi ChandiramaniApril 7 at 10:54 AM
Controlled by my mouse
 Sachi ChandiramaniApril 7 at 8:36 AM
Sachi ChandiramaniApril 7 at 8:36 AM
 Sachi ChandiramaniApril 7 at 8:29 AM
Sachi ChandiramaniApril 7 at 8:29 AM
 Jane LeeApril 7 at 8:15 AM
Jane LeeApril 7 at 8:15 AM
 Jane LeeApril 7 at 7:58 AM
Jane LeeApril 7 at 7:58 AM
 Jane LeeApril 7 at 7:17 AM
Jane LeeApril 7 at 7:17 AM
 Jane LeeApril 7 at 6:36 AM
Jane LeeApril 7 at 6:36 AM

tfw you got something recorded via screen capture but it's too big to be uploaded.
 Amber ChenApril 7 at 6:30 AM
Amber ChenApril 7 at 6:30 AM
Some protocol fun :D
 Sachi ChandiramaniApril 7 at 5:37 AM
Sachi ChandiramaniApril 7 at 5:37 AM
Took a bit to read the chapters. Also used Vuo's examples as a starting point! Hopefully it w…
 Sachi ChandiramaniApril 7 at 5:34 AM
Sachi ChandiramaniApril 7 at 5:34 AM
 Jennifer LeeApril 7 at 5:26 AM
Jennifer LeeApril 7 at 5:26 AM


I got it to work work work! (well sort of. It won't draw lines, but it will draw dots of diff…
 Talia CottonApril 7 at 5:02 AM
Talia CottonApril 7 at 5:02 AM
 Jennifer LeeApril 7 at 5:00 AM
Jennifer LeeApril 7 at 5:00 AM
Simple cube adding receive mouse moves to control the rotation
 Jennifer LeeApril 7 at 4:34 AM
Jennifer LeeApril 7 at 4:34 AM

Lights on image controlled by mouse scrolls... sort of like a flashlight! :D
 Amber ChenApril 7 at 4:32 AM
Amber ChenApril 7 at 4:32 AM
Ooooooooo....
 Jonathan KhoApril 7 at 4:18 AM
Jonathan KhoApril 7 at 4:18 AM
Using live sound and noise
 Jennifer LeeApril 7 at 4:15 AM
Jennifer LeeApril 7 at 4:15 AM
Explosion
 Jonathan KhoApril 7 at 3:56 AM
Jonathan KhoApril 7 at 3:56 AM
The spot will appear when there's a click. Double or triple click will make the spot larger.…
 Amber ChenApril 7 at 3:26 AM
Amber ChenApril 7 at 3:26 AM
 Sachi ChandiramaniApril 7 at 2:46 AM
Sachi ChandiramaniApril 7 at 2:46 AM
 Bateel SaberApril 7 at 2:18 AM
Bateel SaberApril 7 at 2:18 AM
 Bateel SaberApril 7 at 2:14 AM
Bateel SaberApril 7 at 2:14 AM
 Sachi ChandiramaniApril 7 at 1:39 AM
Sachi ChandiramaniApril 7 at 1:39 AM
Feeling dizzy...........
 Sachi ChandiramaniApril 7 at 1:33 AM
Sachi ChandiramaniApril 7 at 1:33 AM
Adding some turtle graphics to the sketches this week 😁
 Sachi ChandiramaniApril 7 at 1:16 AM
Sachi ChandiramaniApril 7 at 1:16 AM


Added an audio, but can't actually hear to it. This sketch is creating a kaleidoscope image w…
 Dorothy CruzApril 7 at 1:14 AM
Dorothy CruzApril 7 at 1:14 AM
Played with more filters, this time using time to animate rather than mouse.
 Jonathan KhoApril 7 at 12:55 AM
Jonathan KhoApril 7 at 12:55 AM
Using protocols and playing with images.
 Jonathan KhoApril 7 at 12:09 AM
Jonathan KhoApril 7 at 12:09 AM

Experimenting with audio visuals. Right now the audio is coming from the microphone.
 Dorothy CruzApril 6 at 11:26 PM
Dorothy CruzApril 6 at 11:26 PM
First test.
Used mouse move and scroll data to alter twirl.
 Jonathan KhoApril 6 at 11:04 PM
Jonathan KhoApril 6 at 11:04 PM

Getting mathy again... Tried to build a visual representation of 3D parametric equations. (For ex…
 Talia CottonApril 6 at 6:38 PM
Talia CottonApril 6 at 6:38 PM
Bruh.
 Amber ChenApril 6 at 4:32 PM
Amber ChenApril 6 at 4:32 PM
Part One of working on a "Draw" thing. User controls color and size of brush from arrow…
 Talia CottonApril 6 at 5:28 AM
Talia CottonApril 6 at 5:28 AM

image trailing of birds flying
 Jennifer LeeApril 6 at 5:10 AM
Jennifer LeeApril 6 at 5:10 AM
little sphere
 S. I.April 6 at 3:07 AM
S. I.April 6 at 3:07 AM
(that's supposed to be a click). // Just some play with random/position/size…
 Talia CottonApril 6 at 2:47 AM
Talia CottonApril 6 at 2:47 AM

Made a Vuo version of the already existing iphone finger battle game! Worked for 2 hours…
 Talia CottonApril 6 at 12:21 AM
Talia CottonApril 6 at 12:21 AM

Tried to use the Protocol and to export the video from the program. (1) The scale of the halftone…
 Dorothy CruzApril 5 at 10:22 PM
Dorothy CruzApril 5 at 10:22 PM

CMYK Halftone process of an image. The image was supposed to be a gif, but it doesn't play.…
 Dorothy CruzApril 5 at 9:09 PM
Dorothy CruzApril 5 at 9:09 PM
manipulating video // source: clapping music ballet, steve reich, 1972
 S. I.April 5 at 3:43 AM
S. I.April 5 at 3:43 AM
oscilloscope // made in pure data // code help: nicolas maigret
 S. I.April 4 at 10:11 PM
S. I.April 4 at 10:11 PM

Working a little bit with the basics of vuo.
 Dorothy CruzApril 4 at 9:19 PM
Dorothy CruzApril 4 at 9:19 PM
Playing with Vuo tools by applying effects and events on an image. The image was one of the turtl…
 Amber ChenApril 4 at 7:33 PM
Amber ChenApril 4 at 7:33 PM


forgot to post this last week - turtle graphics // trying to make an organic texture // image 3 s…
 S. I.April 3 at 12:53 AM
S. I.April 3 at 12:53 AM
Stairway To Heaven
 Gabriel MesterMarch 31 at 7:46 PM
Gabriel MesterMarch 31 at 7:46 PM


3D-looking shape thing. User controls parameters: number of sides on shape, how big the base shap…
 Talia CottonMarch 31 at 7:46 PM
Talia CottonMarch 31 at 7:46 PM

even more mathy. Wrote a function that isn't fully working yet but still does a lot.…
 Talia CottonMarch 31 at 7:45 PM
Talia CottonMarch 31 at 7:45 PM
very mathy. Inspired by the many differently-sized and positioned circles that came out when stu…
 Talia CottonMarch 31 at 7:45 PM
Talia CottonMarch 31 at 7:45 PM
Clockwork Pink
 Gabriel MesterMarch 31 at 7:45 PM
Gabriel MesterMarch 31 at 7:45 PM
Spring Sprinkle
 Gabriel MesterMarch 31 at 7:45 PM
Gabriel MesterMarch 31 at 7:45 PM
"Chewy, light speed, now!"
 Gabriel MesterMarch 31 at 7:44 PM
Gabriel MesterMarch 31 at 7:44 PM
Lotus Flower
 Gabriel MesterMarch 31 at 7:43 PM
Gabriel MesterMarch 31 at 7:43 PM
Giraffe----Only using: myTurtle.penUp, myTurtle.moveTo, myTurtle.moveForward, myTurtle.turnLeft…
 Danielle SobelMarch 31 at 7:35 PM
Danielle SobelMarch 31 at 7:35 PM
 Sachi ChandiramaniMarch 31 at 7:15 PM
Sachi ChandiramaniMarch 31 at 7:15 PM
 Sachi ChandiramaniMarch 31 at 7:03 PM
Sachi ChandiramaniMarch 31 at 7:03 PM

This is how my week looked like.
 Dorothy CruzMarch 31 at 7:03 PM
Dorothy CruzMarch 31 at 7:03 PM
 Sachi ChandiramaniMarch 31 at 6:49 PM
Sachi ChandiramaniMarch 31 at 6:49 PM

pre-rendered animation
 S. I.March 31 at 6:40 PM
S. I.March 31 at 6:40 PM

This is so much fun, I thought I'd share this link with you all-- its an online spirograph ma…
 Danielle SobelMarch 31 at 5:23 PM
Danielle SobelMarch 31 at 5:23 PM
For this study example, I wanted to add flowers (leaves) to the branches.
 Danielle SobelMarch 31 at 3:40 PM
Danielle SobelMarch 31 at 3:40 PM
I was playing with a spiralgraph for this sketch. I made it a random color, so I made a few adjus…
 Danielle SobelMarch 31 at 2:20 PM
Danielle SobelMarch 31 at 2:20 PM
turtle clock
 S. I.March 31 at 3:59 AM
S. I.March 31 at 3:59 AM

 Dorothy CruzMarch 31 at 3:53 AM
Dorothy CruzMarch 31 at 3:53 AM

Some random things.
 Dorothy CruzMarch 31 at 2:38 AM
Dorothy CruzMarch 31 at 2:38 AM
Made from the google wallet logo
 Jennifer LeeMarch 31 at 12:45 AM
Jennifer LeeMarch 31 at 12:45 AM
 Jennifer LeeMarch 31 at 12:25 AM
Jennifer LeeMarch 31 at 12:25 AM
Turtle Graphics with an image :)
--- CODE BELOW
var myTurtle; var startFrame; var u…
 Danielle SobelMarch 30 at 9:57 PM
Danielle SobelMarch 30 at 9:57 PM
 Jane LeeMarch 30 at 5:26 AM
Jane LeeMarch 30 at 5:26 AM
 Jane LeeMarch 30 at 4:57 AM
Jane LeeMarch 30 at 4:57 AM
 Jane LeeMarch 30 at 4:46 AM
Jane LeeMarch 30 at 4:46 AM
a superstudio-esque sketch // photo from National Geographic November 1952 issue // it's not…
 S. I.March 30 at 4:36 AM
S. I.March 30 at 4:36 AM
Go Turtle!
 Jane LeeMarch 30 at 4:26 AM
Jane LeeMarch 30 at 4:26 AM
 Jane LeeMarch 30 at 3:49 AM
Jane LeeMarch 30 at 3:49 AM
 Jane LeeMarch 30 at 3:34 AM
Jane LeeMarch 30 at 3:34 AM
I started with a turtle face but halfway through it looks more like a gorilla so I changed plan.…
 Amber ChenMarch 30 at 2:58 AM
Amber ChenMarch 30 at 2:58 AM


I promise I will code. These sketches were made by hand using a spirograph.
 Dorothy CruzMarch 30 at 1:25 AM
Dorothy CruzMarch 30 at 1:25 AM
Not at all the result I was going for. I guess a vector based object oriented approach would be m…
 Kim KoehlerMarch 29 at 5:54 PM
Kim KoehlerMarch 29 at 5:54 PM


Generating sketch-like drawings. The last one with black and white is the initial process after g…
 Amber ChenMarch 29 at 5:20 AM
Amber ChenMarch 29 at 5:20 AM


(continuation of last post) This should be a better visualization of what I'm struggling with…
 Talia CottonMarch 29 at 3:40 AM
Talia CottonMarch 29 at 3:40 AM


Experimentation less with shape, more with color. I made the stroke color go up within the loop b…
 Talia CottonMarch 29 at 3:13 AM
Talia CottonMarch 29 at 3:13 AM

How many seeds are there in these fields of dandelion... oh wait.
 Amber ChenMarch 28 at 4:45 PM
Amber ChenMarch 28 at 4:45 PM
tried to make a loading animation using spirographs
 Jennifer LeeMarch 28 at 7:36 AM
Jennifer LeeMarch 28 at 7:36 AM
pre-rendered animation
 Jennifer LeeMarch 28 at 7:06 AM
Jennifer LeeMarch 28 at 7:06 AM
 Jennifer LeeMarch 28 at 6:29 AM
Jennifer LeeMarch 28 at 6:29 AM
 Bateel SaberMarch 27 at 10:42 PM
Bateel SaberMarch 27 at 10:42 PM

 Bateel SaberMarch 27 at 10:41 PM
Bateel SaberMarch 27 at 10:41 PM


the tiny sketch became these things // takes a lot of time to render, working on making a real-ti…
 S. I.March 26 at 11:46 PM
S. I.March 26 at 11:46 PM
a tiny sketch
 S. I.March 26 at 2:02 AM
S. I.March 26 at 2:02 AM
what my last sketch turned into - unexpected, sort of soviet-constructivism look
 S. I.March 26 at 1:59 AM
S. I.March 26 at 1:59 AM


Using turtle graphics for drawing tile graphics at random. Last one was penUp whenever the turtle…
 Amber ChenMarch 25 at 11:47 PM
Amber ChenMarch 25 at 11:47 PMIMPRESSIVE STUFF GUYS! MISS YOUR BEAUTIFUL FACES.
 Brinna ThomsenMarch 25 at 1:48 AM
Brinna ThomsenMarch 25 at 1:48 AM
 Bateel SaberMarch 25 at 1:28 AM
Bateel SaberMarch 25 at 1:28 AM


Scribbles
 Dorothy CruzMarch 25 at 12:35 AM
Dorothy CruzMarch 25 at 12:35 AM
continuing with a previous sketch - now little annoying spirals follow the mouse around
 S. I.March 25 at 12:11 AM
S. I.March 25 at 12:11 AM
the spiral post
 S. I.March 24 at 11:40 PM
S. I.March 24 at 11:40 PM
tried to draw an owl
 S. I.March 24 at 2:57 AM
S. I.March 24 at 2:57 AM
 Bateel SaberMarch 24 at 1:02 AM
Bateel SaberMarch 24 at 1:02 AM


 Bateel SaberMarch 24 at 12:01 AM
Bateel SaberMarch 24 at 12:01 AM
trying to recreate one of my early sketches in this class but using turtle graphics // used the i…
 S. I.March 23 at 11:54 PM
S. I.March 23 at 11:54 PM

For a project I'm working on, I need a way to create an input map that would tell me how far…
 Justin BakseMarch 23 at 4:57 PM
Justin BakseMarch 23 at 4:57 PM
Animal Head Challenge
 Jonathan KhoMarch 23 at 7:41 AM
Jonathan KhoMarch 23 at 7:41 AM
 Bateel SaberMarch 23 at 2:52 AM
Bateel SaberMarch 23 at 2:52 AM
blue dot 2.0 (using turtle graphics)
 S. I.March 23 at 1:38 AM
S. I.March 23 at 1:38 AM


Obligatory spiral post
 Amber ChenMarch 22 at 9:26 PM
Amber ChenMarch 22 at 9:26 PM
Not a new post.
Couldn't add more than 3 images in a post. An attempt to match the co…
 Jonathan KhoMarch 22 at 8:38 AM
Jonathan KhoMarch 22 at 8:38 AM


Used spiral to create roughly the effect of the scene where Coraline descends into the "othe…
 Jonathan KhoMarch 22 at 8:15 AM
Jonathan KhoMarch 22 at 8:15 AM
Her name because it's easy. Tried using opacity to give it a somewhat calligraphic feel. Gave…
 Jonathan KhoMarch 22 at 7:25 AM
Jonathan KhoMarch 22 at 7:25 AM
Figured out the solution to my previous problem. Conclusion: there is no way to slow the process…
 Jonathan KhoMarch 22 at 6:38 AM
Jonathan KhoMarch 22 at 6:38 AM
A sketch from the Generating Animation week which I didn't get running back then. Using Easin…
 Kim KoehlerMarch 20 at 5:34 AM
Kim KoehlerMarch 20 at 5:34 AM

Was trying to figure out how to show the process of drawing the hexagon instead of having the dra…
 Jonathan KhoMarch 20 at 5:09 AM
Jonathan KhoMarch 20 at 5:09 AM
image source: photo of james turrell's "perceptual cell"
 S. I.March 17 at 8:50 PM
S. I.March 17 at 8:50 PM
Mesm Records Exp.
 Gabriel MesterMarch 17 at 7:52 PM
Gabriel MesterMarch 17 at 7:52 PM
Tweaking Fantin-Latour
 Gabriel MesterMarch 17 at 7:34 PM
Gabriel MesterMarch 17 at 7:34 PM
 S. I.March 17 at 7:18 PM
S. I.March 17 at 7:18 PMJONATHAN KHO THANK YOU LETS TALK
 S. I.March 17 at 7:16 PM
S. I.March 17 at 7:16 PM


Process
 Gabriel MesterMarch 17 at 7:15 PM
Gabriel MesterMarch 17 at 7:15 PM


 Bateel SaberMarch 17 at 7:01 PM
Bateel SaberMarch 17 at 7:01 PM
Sani was this what you were trying to get to? Projected dots?
SANI HERE IS THE CODE:
<… Jonathan KhoMarch 17 at 6:58 PM
Jonathan KhoMarch 17 at 6:58 PM
Auto-portrait
 Gabriel MesterMarch 17 at 6:57 PM
Gabriel MesterMarch 17 at 6:57 PM


Tried out some Chromatic Aberration. // The process was pretty straightforward: Load the image t…
 Talia CottonMarch 17 at 6:32 PM
Talia CottonMarch 17 at 6:32 PM
Glitch
 Gabriel MesterMarch 17 at 6:13 PM
Gabriel MesterMarch 17 at 6:13 PM


failed sketches that i spent too much time on, but didn't do what i wanted them to (can they…
 S. I.March 17 at 4:59 PM
S. I.March 17 at 4:59 PM
 Jennifer LeeMarch 17 at 4:43 PM
Jennifer LeeMarch 17 at 4:43 PM
 Jennifer LeeMarch 17 at 4:42 PM
Jennifer LeeMarch 17 at 4:42 PM
Used pixels and quads
 Jennifer LeeMarch 17 at 4:42 PM
Jennifer LeeMarch 17 at 4:42 PM
tile set
 Jennifer LeeMarch 17 at 4:41 PM
Jennifer LeeMarch 17 at 4:41 PM
 Jennifer LeeMarch 17 at 4:39 PM
Jennifer LeeMarch 17 at 4:39 PM
Studying Justins study example :) First attempt.
 Danielle SobelMarch 17 at 2:43 PM
Danielle SobelMarch 17 at 2:43 PM
Image as and Input
 Sachi ChandiramaniMarch 17 at 11:53 AM
Sachi ChandiramaniMarch 17 at 11:53 AM

 Jane LeeMarch 17 at 9:57 AM
Jane LeeMarch 17 at 9:57 AM

Third iteration of a series of experiments that are to lead to the synthesis of a parametric flow…
 Enayet KabirMarch 17 at 9:38 AM
Enayet KabirMarch 17 at 9:38 AM
 Jane LeeMarch 17 at 9:19 AM
Jane LeeMarch 17 at 9:19 AM
Second iteration of a series of experiments that are to lead to the synthesis of a parametric flo…
 Enayet KabirMarch 17 at 9:16 AM
Enayet KabirMarch 17 at 9:16 AM
First iteration of a series of experiments that are to lead to the synthesis of a parametric flow…
 Enayet KabirMarch 17 at 9:12 AM
Enayet KabirMarch 17 at 9:12 AM
 Jane LeeMarch 17 at 9:07 AM
Jane LeeMarch 17 at 9:07 AM


These ones are all cheating because I did them a long time ago, but I thought I'd share anywa…
 Enayet KabirMarch 17 at 9:04 AM
Enayet KabirMarch 17 at 9:04 AM
Yet another pixel sorty kinda thing. The source image is a 3d render I did a while ago.
 Enayet KabirMarch 17 at 9:00 AM
Enayet KabirMarch 17 at 9:00 AM

Pixel sorting animation on the same image as the last sketch. The source image is clearly visible…
 Enayet KabirMarch 17 at 8:59 AM
Enayet KabirMarch 17 at 8:59 AM
Pointillism kinda effect on an image I made in the past
 Enayet KabirMarch 17 at 8:57 AM
Enayet KabirMarch 17 at 8:57 AM
glitch code help from Corrupt.video Processing code by Recyclism aka Benjamin Gaulon // images fr…
 S. I.March 17 at 8:31 AM
S. I.March 17 at 8:31 AM
 Jane LeeMarch 17 at 8:25 AM
Jane LeeMarch 17 at 8:25 AM
not really changing the image appearance (yet) // a sketch that shows your face only when your ey…
 S. I.March 17 at 8:23 AM
S. I.March 17 at 8:23 AM
Pixel sort animation on another aerial view of a cityscape
 Enayet KabirMarch 17 at 8:17 AM
Enayet KabirMarch 17 at 8:17 AM

Two slightly different versions of a pixel sorted aerial view of a city.
 Enayet KabirMarch 17 at 7:27 AM
Enayet KabirMarch 17 at 7:27 AM
 Sachi ChandiramaniMarch 17 at 7:10 AM
Sachi ChandiramaniMarch 17 at 7:10 AM

In an attempt to use get and set to make Mickey into a gradient, I got this weird thing ^ will co…
 Sachi ChandiramaniMarch 17 at 6:41 AM
Sachi ChandiramaniMarch 17 at 6:41 AM
Sink or Swim?
Inspired + help from Justin's code:
 Sachi ChandiramaniMarch 17 at 6:09 AM
Sachi ChandiramaniMarch 17 at 6:09 AM

I messed up ouroboros chicken :') Probably should have went with a code that changes shape mo…
 Amber ChenMarch 17 at 5:21 AM
Amber ChenMarch 17 at 5:21 AM


Tetris V.3 I am still missing the random shapes.
 Dorothy CruzMarch 17 at 4:55 AM
Dorothy CruzMarch 17 at 4:55 AM
P5 and Photoshop
 Sachi ChandiramaniMarch 17 at 2:33 AM
Sachi ChandiramaniMarch 17 at 2:33 AM

Played with micLevel to change the size of the dots.
UPDATE: Would choose rect() over elli…
 Jonathan KhoMarch 17 at 2:10 AM
Jonathan KhoMarch 17 at 2:10 AM

Still playing with the camera.
Used beginShape(QUAD_STRIP) so it links the looped quads to…
 Jonathan KhoMarch 17 at 1:36 AM
Jonathan KhoMarch 17 at 1:36 AM
Panda Jump Iteration 2. This works a little better than the last one but I'm not sure its wha…
 Danielle SobelMarch 17 at 12:40 AM
Danielle SobelMarch 17 at 12:40 AM
The plan was to make a panda jumping: If you look really REALLY closely on the bottom right hand…
 Danielle SobelMarch 16 at 11:54 PM
Danielle SobelMarch 16 at 11:54 PM


Thanks Danielle Sobel for the inspiration :D
Tried to replicate an infra red camera. Don&#…
 Jonathan KhoMarch 16 at 11:07 PM
Jonathan KhoMarch 16 at 11:07 PM
Got to successfully render a video :') .... The problem all this time was that my image was t…
 Jonathan KhoMarch 16 at 9:32 PM
Jonathan KhoMarch 16 at 9:32 PM
 Bateel SaberMarch 16 at 8:57 PM
Bateel SaberMarch 16 at 8:57 PM


Trying to make fire! Flames brightness determined by the lightness of the pixel of image.... Fee…
 Amber ChenMarch 16 at 4:48 PM
Amber ChenMarch 16 at 4:48 PM


Generated some flags with pixels:
-Dominican Republic -Cuba -Puerto Rico
 Dorothy CruzMarch 16 at 4:21 PM
Dorothy CruzMarch 16 at 4:21 PM

Grass Drawing
 Jane LeeMarch 16 at 8:30 AM
Jane LeeMarch 16 at 8:30 AM
Napoleon. Tried to use noise() to animate it but it got too laggy...
 Jonathan KhoMarch 16 at 4:13 AM
Jonathan KhoMarch 16 at 4:13 AM


Caution: Look from a distance or shrink the image to prevent dizziness. Using image as input and…
 Amber ChenMarch 16 at 2:13 AM
Amber ChenMarch 16 at 2:13 AM

Tetris V2. I still want to be able to remove a line when it is complete and to generate random sh…
 Dorothy CruzMarch 16 at 1:55 AM
Dorothy CruzMarch 16 at 1:55 AM

 Bateel SaberMarch 16 at 12:58 AM
Bateel SaberMarch 16 at 12:58 AM
SNOWDAY! Pixel by Pixel. Was fun to calculate which "column" already had snow on the gr…
 Talia CottonMarch 15 at 11:40 PM
Talia CottonMarch 15 at 11:40 PM


Plan: Load an image (heart) and process its pixels. I think I still want to play with more color…
 Danielle SobelMarch 15 at 11:10 PM
Danielle SobelMarch 15 at 11:10 PM
 Bateel SaberMarch 15 at 8:06 PM
Bateel SaberMarch 15 at 8:06 PM


 Bateel SaberMarch 15 at 8:06 PM
Bateel SaberMarch 15 at 8:06 PM


Plan: Learning from Daniel Shiffman Tutorials.
Goal for next sketch: Modify a few of these…
 Danielle SobelMarch 15 at 3:40 PM
Danielle SobelMarch 15 at 3:40 PM


meh... more experiments...
NOW I'm gonna spend more time on drawing an image by scrat…
 Talia CottonMarch 15 at 3:39 AM
Talia CottonMarch 15 at 3:39 AM
01 Generate an image from scratch: pixel by pixel.
 S. I.March 15 at 3:06 AM
S. I.March 15 at 3:06 AM


I took a 2D image(last img) and converted the pixels of it into vertices of a mesh. I then set th…
 Kim KoehlerMarch 15 at 12:49 AM
Kim KoehlerMarch 15 at 12:49 AM
Thought this would be a good week to get into Fragment Shaders.
 Kim KoehlerMarch 15 at 12:38 AM
Kim KoehlerMarch 15 at 12:38 AM


Halftone fun. Image as Input Source, 2. Not satisfied with the skill level of this... ellipses ar…
 Talia CottonMarch 15 at 12:17 AM
Talia CottonMarch 15 at 12:17 AM

Image as Input Source. Shown is (1) Output Image, (2) Input Image. Goddamn phantom strok…
 Talia CottonMarch 14 at 10:51 PM
Talia CottonMarch 14 at 10:51 PM


Pixels by using images. Used it on the ink wash paintings for the trippy style.
 Amber ChenMarch 14 at 5:56 PM
Amber ChenMarch 14 at 5:56 PM

Trying to do a Tetris. I still need to get it to generate random shapes, not only one pixel and…
 Dorothy CruzMarch 14 at 4:21 PM
Dorothy CruzMarch 14 at 4:21 PM
It worked out better with this typeface and some edits to the code. There is still something wier…
 Kim KoehlerMarch 13 at 9:14 PM
Kim KoehlerMarch 13 at 9:14 PM


I encountered this result while trying to do one of the challenges.
 Dorothy CruzMarch 13 at 8:37 PM
Dorothy CruzMarch 13 at 8:37 PM
not exactly sure how this happened // tried to read pixels of a video instead of an image + apply…
 S. I.March 13 at 4:52 AM
S. I.March 13 at 4:52 AM
I made my drawing tool draw the black pixels from a png file. Didn't work out to well in this…
 Kim KoehlerMarch 12 at 4:56 PM
Kim KoehlerMarch 12 at 4:56 PM
Using all pixels to draw this sketch. Inspired from both in-class challenge of noise and the the…
 Amber ChenMarch 12 at 6:37 AM
Amber ChenMarch 12 at 6:37 AM

Still not there, but I'm putting it aside to work on some cool pixels. For a real lau…
 Talia CottonMarch 11 at 7:16 PM
Talia CottonMarch 11 at 7:16 PM
 S. I.March 10 at 11:25 PM
S. I.March 10 at 11:25 PM
 Gabriel MesterMarch 10 at 8:27 PM
Gabriel MesterMarch 10 at 8:27 PM

(1.5/2) Not exactly what I was going for but... progress!!! (???) I'm so close I know it...
 Talia CottonMarch 10 at 8:25 PM
Talia CottonMarch 10 at 8:25 PM
Wriggling my old project with sin()
 Jonathan KhoMarch 10 at 8:22 PM
Jonathan KhoMarch 10 at 8:22 PM
still from animation
 S. I.March 10 at 8:13 PM
S. I.March 10 at 8:13 PM
Using var s = sin(frameCount/targetFrameRate2PI);
 Danielle SobelMarch 10 at 7:59 PM
Danielle SobelMarch 10 at 7:59 PM
made in unity - attempt at banner and to visualize audio from Devo song
 S. I.March 10 at 7:22 PM
S. I.March 10 at 7:22 PM


 Gabriel MesterMarch 10 at 7:20 PM
Gabriel MesterMarch 10 at 7:20 PM


 Gabriel MesterMarch 10 at 7:27 AM
Gabriel MesterMarch 10 at 7:27 AM


-Insert epic space music in background-
... In the end at 2AM all it looks like is just th…
 Amber ChenMarch 10 at 7:24 AM
Amber ChenMarch 10 at 7:24 AM
used push() and pop() so I can use colorMode(HSB) for the quads and RGB for the background.
 Jennifer LeeMarch 10 at 7:24 AM
Jennifer LeeMarch 10 at 7:24 AM

Playing off of my sine wave sketch from last week.
 Sachi ChandiramaniMarch 10 at 6:55 AM
Sachi ChandiramaniMarch 10 at 6:55 AM
 Jane LeeMarch 10 at 6:53 AM
Jane LeeMarch 10 at 6:53 AM


Could've been smoother if I exported frames but apparently this happened... :( I'm so don…
 Jonathan KhoMarch 10 at 6:17 AM
Jonathan KhoMarch 10 at 6:17 AM
 Sachi ChandiramaniMarch 10 at 6:13 AM
Sachi ChandiramaniMarch 10 at 6:13 AM
This one had too many frames. My computer was not happy about it....
 Sachi ChandiramaniMarch 10 at 5:54 AM
Sachi ChandiramaniMarch 10 at 5:54 AM
 Jane LeeMarch 10 at 5:46 AM
Jane LeeMarch 10 at 5:46 AM
 Jane LeeMarch 10 at 5:03 AM
Jane LeeMarch 10 at 5:03 AM
 Gabriel MesterMarch 10 at 4:34 AM
Gabriel MesterMarch 10 at 4:34 AM


Exploring blendMode(DIFFERENCE); trying to see get better colors. I like these combinations.
 Dorothy CruzMarch 10 at 4:29 AM
Dorothy CruzMarch 10 at 4:29 AM
It kind of has a beginning, but it doesn't really have an end. The shape isn't exactly wh…
 Sachi ChandiramaniMarch 10 at 4:26 AM
Sachi ChandiramaniMarch 10 at 4:26 AM
in progress sketch, trying to match up the triangles!
 Danielle SobelMarch 10 at 3:34 AM
Danielle SobelMarch 10 at 3:34 AM

 Gabriel MesterMarch 10 at 3:20 AM
Gabriel MesterMarch 10 at 3:20 AM
Sun and Moon. Using Sin, frameCount, and light directions
 Danielle SobelMarch 10 at 2:30 AM
Danielle SobelMarch 10 at 2:30 AM

(1/2) Working with acceleration/velocity to try to get a "real-life" feel... Next I'…
 Talia CottonMarch 10 at 1:26 AM
Talia CottonMarch 10 at 1:26 AM
 Jane LeeMarch 10 at 12:13 AM
Jane LeeMarch 10 at 12:13 AM


I remade it to become this cool painting tool.
 Kim KoehlerMarch 9 at 10:47 PM
Kim KoehlerMarch 9 at 10:47 PM
Improved latency and it now gives you different forms everytime, depending on you mouse speed..
 Kim KoehlerMarch 9 at 10:23 PM
Kim KoehlerMarch 9 at 10:23 PM
Slowly reaching the point which I actually miss the lag and delay.... :(
 Amber ChenMarch 9 at 10:07 PM
Amber ChenMarch 9 at 10:07 PM
 Jane LeeMarch 9 at 7:34 AM
Jane LeeMarch 9 at 7:34 AM
500 frames! never again. Don't know why its so choppy.
 Jennifer LeeMarch 9 at 6:21 AM
Jennifer LeeMarch 9 at 6:21 AM
Downvote/Download. For when it takes longer to render than to actually code.
 Talia CottonMarch 9 at 5:42 AM
Talia CottonMarch 9 at 5:42 AM
IT'S LITTTTTTTTTTTTT!!!!! This used to be my jam yo every time I get on the interwebz
…
 Jonathan KhoMarch 9 at 5:26 AM
Jonathan KhoMarch 9 at 5:26 AM
Bumper.
 Talia CottonMarch 9 at 4:47 AM
Talia CottonMarch 9 at 4:47 AM


Ellipse coordinates travelling on Noise() with low opacity and blendMode(ADD), basically it trace…
 Jonathan KhoMarch 9 at 4:09 AM
Jonathan KhoMarch 9 at 4:09 AM
Compform bumper challenge
Used sin for the squares(they're actually ellipses that were…
 Jennifer LeeMarch 9 at 4:06 AM
Jennifer LeeMarch 9 at 4:06 AM

Sniper aim + shoot. Sadly lost too much quality when compressed.
 Kim KoehlerMarch 9 at 4:01 AM
Kim KoehlerMarch 9 at 4:01 AM

Holy Crap!!!!
Don't ever work with 3D if you don't have the patience for it. Anima…
 Jonathan KhoMarch 9 at 3:33 AM
Jonathan KhoMarch 9 at 3:33 AM
Trying out blendMode.
 Jennifer LeeMarch 9 at 3:04 AM
Jennifer LeeMarch 9 at 3:04 AM
 Jennifer LeeMarch 9 at 2:09 AM
Jennifer LeeMarch 9 at 2:09 AM
Another "boom-box", now using Metronomy - Peter's Pan.
 Dorothy CruzMarch 9 at 1:44 AM
Dorothy CruzMarch 9 at 1:44 AM
In the process of making a bumper using this technique... Got stuck looking for a way to find whe…
 Talia CottonMarch 8 at 11:28 PM
Talia CottonMarch 8 at 11:28 PM
"Boom-box" Trying out WEBGL for the first time.
- I wish I could control th…
 Dorothy CruzMarch 8 at 10:49 PM
Dorothy CruzMarch 8 at 10:49 PM
 Bateel SaberMarch 8 at 9:12 PM
Bateel SaberMarch 8 at 9:12 PM


So... this happened! I will continue exploring this. I am using sin (kinda understand what is doi…
 Dorothy CruzMarch 8 at 7:20 PM
Dorothy CruzMarch 8 at 7:20 PM


I was stuck trying to make something specific for a bumper that I even forgot what I was trying t…
 Dorothy CruzMarch 8 at 5:04 PM
Dorothy CruzMarch 8 at 5:04 PM
Practice really trying to get a handle on timing animation right. I didn't export this movie…
 Talia CottonMarch 8 at 5:52 AM
Talia CottonMarch 8 at 5:52 AM
I like some of what is happening in this, but I'd like to change a few things.
- I…
 Justin BakseMarch 8 at 4:53 AM
Justin BakseMarch 8 at 4:53 AM

So... I can explain about the multiple versions.... The first one is shown on Safari, but as soon…
 Amber ChenMarch 8 at 3:10 AM
Amber ChenMarch 8 at 3:10 AM
1st Animation using P5-- used rotate, push, pop
 Danielle SobelMarch 8 at 12:09 AM
Danielle SobelMarch 8 at 12:09 AM
 Bateel SaberMarch 7 at 11:31 PM
Bateel SaberMarch 7 at 11:31 PM


week 5 // sine wave continued // high res still saved with saveFrame() + video shows how the imag…
 S. I.March 7 at 10:57 PM
S. I.March 7 at 10:57 PM
 Bateel SaberMarch 7 at 5:07 AM
Bateel SaberMarch 7 at 5:07 AM

Recreated an old sketch from another class with what was learned in this class (mostly noise and…
 Amber ChenMarch 7 at 4:30 AM
Amber ChenMarch 7 at 4:30 AM
week 5 // using sine wave
 S. I.March 7 at 12:02 AM
S. I.March 7 at 12:02 AM

A grid of dots, size modulated by sin(), noise(), and a hand made bitma…
 Justin BakseMarch 6 at 9:12 PM
Justin BakseMarch 6 at 9:12 PM
Better fireworks. Improved Random, Noise and Sin functions iterating over colors and movements.
 Kim KoehlerMarch 6 at 7:55 PM
Kim KoehlerMarch 6 at 7:55 PM
 Bateel SaberMarch 6 at 4:00 AM
Bateel SaberMarch 6 at 4:00 AM


Trying out the frame exporting in some old sketches. First, I wanted to see how much of the actua…
 Dorothy CruzMarch 6 at 2:52 AM
Dorothy CruzMarch 6 at 2:52 AM

 Amber ChenMarch 6 at 2:46 AM
Amber ChenMarch 6 at 2:46 AM
Fireworks using a subtle noise and sin and cos waves in Cinder.
 Kim KoehlerMarch 6 at 12:49 AM
Kim KoehlerMarch 6 at 12:49 AM
 Bateel SaberMarch 6 at 12:12 AM
Bateel SaberMarch 6 at 12:12 AM
(3/3) What's added: (1) The same paper edges from noise from the noise week.…
 Talia CottonMarch 4 at 3:40 AM
Talia CottonMarch 4 at 3:40 AM


(2/3) [PIC 1:] Thanks to lots of help from Justin, and to some…
 Talia CottonMarch 4 at 3:34 AM
Talia CottonMarch 4 at 3:34 AM


(1/3) Continuing the attempt to resolve the issues for the treasure map last wee…
 Talia CottonMarch 4 at 3:31 AM
Talia CottonMarch 4 at 3:31 AM
 Jennifer LeeMarch 3 at 8:59 PM
Jennifer LeeMarch 3 at 8:59 PM
function setup(){ createCanvas(windowWidth, windowHeight, WEBGL);
}
function draw…
 Jonathan KhoMarch 3 at 8:41 PM
Jonathan KhoMarch 3 at 8:41 PM
Noisy dripping
 Gabriel MesterMarch 3 at 8:34 PM
Gabriel MesterMarch 3 at 8:34 PM
This is my best sketch so far! Lol. Got stuck struggling with some cos sine waves.
 Kim KoehlerMarch 3 at 8:30 PM
Kim KoehlerMarch 3 at 8:30 PM
Gaussian Random is used to generate the color of the ellipses, such that it looks like it is flas…
 Enayet KabirMarch 3 at 8:07 PM
Enayet KabirMarch 3 at 8:07 PM
This is my version of the line challenge.
 Enayet KabirMarch 3 at 8:02 PM
Enayet KabirMarch 3 at 8:02 PM
Experiment using sine waves with random offsets to modulate each other in a recursive structure.<…
 Enayet KabirMarch 3 at 8:01 PM
Enayet KabirMarch 3 at 8:01 PM
200 different circles are assigned a random color, size and velocity at the start of the program.…
 Enayet KabirMarch 3 at 7:59 PM
Enayet KabirMarch 3 at 7:59 PM
Shooting star with one slider
 Gabriel MesterMarch 3 at 7:52 PM
Gabriel MesterMarch 3 at 7:52 PM
Worm:
Size variation in noise()
 Jonathan KhoMarch 3 at 6:34 PM
Jonathan KhoMarch 3 at 6:34 PM
Built form scratch in paper.js
 Kim KoehlerMarch 3 at 5:30 PM
Kim KoehlerMarch 3 at 5:30 PM

wanted to try new things :) P5 and APIS the first is a data visualization from NYT the second is…
 Danielle SobelMarch 3 at 4:42 PM
Danielle SobelMarch 3 at 4:42 PM



Continuation of the mini game. The amount of fishes and difficulty (amount of enemy jellies) are…
 Amber ChenMarch 3 at 4:36 PM
Amber ChenMarch 3 at 4:36 PM
I can't get rid of the top rectangle arghhh
 Kim KoehlerMarch 3 at 3:15 PM
Kim KoehlerMarch 3 at 3:15 PM
Sliding into Friday.....
 Sachi ChandiramaniMarch 3 at 12:25 PM
Sachi ChandiramaniMarch 3 at 12:25 PM
Help from: https://p5js.org/examples/math…
 Sachi ChandiramaniMarch 3 at 11:54 AM
Sachi ChandiramaniMarch 3 at 11:54 AM
The bloodstream... (because blood can be blue too)
 Sachi ChandiramaniMarch 3 at 10:09 AM
Sachi ChandiramaniMarch 3 at 10:09 AM
 Jane LeeMarch 3 at 9:35 AM
Jane LeeMarch 3 at 9:35 AM
Line Challenge 2
 Jane LeeMarch 3 at 9:10 AM
Jane LeeMarch 3 at 9:10 AM
Line Challenge
 Jane LeeMarch 3 at 8:50 AM
Jane LeeMarch 3 at 8:50 AM
Used random and wanted to see how it is visualized at a larger scale
 Jennifer LeeMarch 3 at 6:49 AM
Jennifer LeeMarch 3 at 6:49 AM
 Jennifer LeeMarch 3 at 6:43 AM
Jennifer LeeMarch 3 at 6:43 AM
my closest attempt to make random placed circles from the center
 Jennifer LeeMarch 3 at 6:38 AM
Jennifer LeeMarch 3 at 6:38 AM
challenge 2- manipulate amplitude to create an illusion of a 3D shaped object looks sort of lik…
 Jennifer LeeMarch 3 at 6:19 AM
Jennifer LeeMarch 3 at 6:19 AM

(Line Challenge)
 Sachi ChandiramaniMarch 3 at 6:17 AM
Sachi ChandiramaniMarch 3 at 6:17 AM
challenge #1
 Jennifer LeeMarch 3 at 6:05 AM
Jennifer LeeMarch 3 at 6:05 AM
 Bateel SaberMarch 3 at 5:47 AM
Bateel SaberMarch 3 at 5:47 AM


Continuation of the Fish Game.
Updates:
- Small fish graphics
- Backgrou…
 Amber ChenMarch 3 at 4:46 AM
Amber ChenMarch 3 at 4:46 AM

(Dot challenge) Almost got it, I think I was missing a piece.
 Sachi ChandiramaniMarch 3 at 4:17 AM
Sachi ChandiramaniMarch 3 at 4:17 AM


Dot Challenge, Vases
 Danielle SobelMarch 3 at 2:08 AM
Danielle SobelMarch 3 at 2:08 AM

 Bateel SaberMarch 3 at 1:41 AM
Bateel SaberMarch 3 at 1:41 AM
 Bateel SaberMarch 3 at 1:20 AM
Bateel SaberMarch 3 at 1:20 AM

First time with Paper.js - drawing clouds
 Danielle SobelMarch 3 at 1:07 AM
Danielle SobelMarch 3 at 1:07 AM


1
 Gabriel MesterMarch 3 at 1:07 AM
Gabriel MesterMarch 3 at 1:07 AM
Built in Cinder with a Pointer structure. Thus, it can run pretty smooth even though its 10 000 p…
 Kim KoehlerMarch 2 at 11:54 PM
Kim KoehlerMarch 2 at 11:54 PM

I can't get the lines to stick. I know what the issue is, but when I try to solve it somethin…
 Dorothy CruzMarch 2 at 11:44 PM
Dorothy CruzMarch 2 at 11:44 PM

Long Project V.2. Now you can make a gradient on the bg and you can manipulate de hsl of the bott…
 Dorothy CruzMarch 2 at 11:07 PM
Dorothy CruzMarch 2 at 11:07 PM


"Line" challenge.
 Dorothy CruzMarch 2 at 10:06 PM
Dorothy CruzMarch 2 at 10:06 PM
Sunrise
 Gabriel MesterMarch 2 at 9:39 PM
Gabriel MesterMarch 2 at 9:39 PM
Centrifuge
 Gabriel MesterMarch 2 at 9:38 PM
Gabriel MesterMarch 2 at 9:38 PM
Fail to implement Noise Cull, instead I did this.
Anyone know how do I control the color o…
 Jonathan KhoMarch 2 at 8:12 PM
Jonathan KhoMarch 2 at 8:12 PM

 Jonathan KhoMarch 2 at 7:10 PM
Jonathan KhoMarch 2 at 7:10 PM
Cactus Thorn party
 Jane LeeMarch 2 at 8:16 AM
Jane LeeMarch 2 at 8:16 AM


Part One: Dot Challenge Dots making weird shapes (Bird, Fish, etc...)
 Jane LeeMarch 2 at 7:26 AM
Jane LeeMarch 2 at 7:26 AM

I'm setting out to make uh..."fish eating other fish to get larger" game? Using ell…
 Amber ChenMarch 2 at 5:33 AM
Amber ChenMarch 2 at 5:33 AM
 Bateel SaberMarch 2 at 5:32 AM
Bateel SaberMarch 2 at 5:32 AM
 Bateel SaberMarch 2 at 5:30 AM
Bateel SaberMarch 2 at 5:30 AM
Dragon
 Jonathan KhoMarch 2 at 4:06 AM
Jonathan KhoMarch 2 at 4:06 AM
Dot challenge evolution - Separate sets of gaussian distributed random values are used to generat…
 Enayet KabirMarch 2 at 3:37 AM
Enayet KabirMarch 2 at 3:37 AM

Long project V. 1 - For now you can only adjust canvas size and background! I will be adding more…
 Dorothy CruzMarch 2 at 1:56 AM
Dorothy CruzMarch 2 at 1:56 AM
First iteration of a piece where I am trying to make a scene where we are looking into the horizo…
 Enayet KabirMarch 2 at 12:09 AM
Enayet KabirMarch 2 at 12:09 AM
Bacteria
 Jonathan KhoMarch 1 at 11:27 PM
Jonathan KhoMarch 1 at 11:27 PM
Perlin noise controls the Z axis coordinate value of the points making up a grid of triangle stri…
 Enayet KabirMarch 1 at 10:29 PM
Enayet KabirMarch 1 at 10:29 PM


Dot Challenge, Bigger Dots, Flowers
 Danielle SobelMarch 1 at 4:39 PM
Danielle SobelMarch 1 at 4:39 PM

Believe me this actually came from the line challenge
 Amber ChenMarch 1 at 2:40 AM
Amber ChenMarch 1 at 2:40 AM
This was the closest I got. Rewrote the thing from scratch in paper.js. Never worked in paper.js…
 Kim KoehlerMarch 1 at 1:43 AM
Kim KoehlerMarch 1 at 1:43 AM
The Dot Challenge is now a broccoli promotion poster.
 Amber ChenFebruary 28 at 1:45 AM
Amber ChenFebruary 28 at 1:45 AM


Dot Challenge. I couldn't quite get the position for the circles, so decided to play a bit wi…
 Dorothy CruzFebruary 27 at 3:52 AM
Dorothy CruzFebruary 27 at 3:52 AM
Line Challenge- Frequency, Amplitude, Time/Speed. I added color.
 Danielle SobelFebruary 27 at 3:26 AM
Danielle SobelFebruary 27 at 3:26 AM


Dot (Ellipse?) Challenge
 Talia CottonFebruary 25 at 3:06 AM
Talia CottonFebruary 25 at 3:06 AM
Line Challenge. (hey guys, use lerp.)
 Talia CottonFebruary 25 at 2:21 AM
Talia CottonFebruary 25 at 2:21 AM


Treasure map: step 2
 Kim KoehlerFebruary 24 at 8:56 PM
Kim KoehlerFebruary 24 at 8:56 PM

Treasure map step 1.
 Kim KoehlerFebruary 24 at 8:55 PM
Kim KoehlerFebruary 24 at 8:55 PM
Using noise to create shooting star projection & ground. Also implemented the min(random) fun…
 Talia CottonFebruary 24 at 7:40 PM
Talia CottonFebruary 24 at 7:40 PM
showing the cloudy perlin noise appearance with a different texture
 Jennifer LeeFebruary 24 at 7:00 PM
Jennifer LeeFebruary 24 at 7:00 PM
trying to use noise generated textures as surfaces for rotating planet things (no 3d texture yet)…
 S. I.February 24 at 5:26 PM
S. I.February 24 at 5:26 PM
Basic Shapes. Noise vs. Random & Rotations
 Danielle SobelFebruary 24 at 4:06 PM
Danielle SobelFebruary 24 at 4:06 PM
more with perlin noise, colours
 S. I.February 24 at 2:14 PM
S. I.February 24 at 2:14 PM
two shapes
 S. I.February 24 at 2:14 PM
S. I.February 24 at 2:14 PM
failed experiment
 S. I.February 24 at 2:13 PM
S. I.February 24 at 2:13 PM
Reworked sketch from week 2 using noise instead of random - this is what I wanted it to look orig…
 S. I.February 24 at 2:11 PM
S. I.February 24 at 2:11 PM
 S. I.February 24 at 2:09 PM
S. I.February 24 at 2:09 PM
simulating water with perlin noise
 Jennifer LeeFebruary 24 at 10:12 AM
Jennifer LeeFebruary 24 at 10:12 AM
 Jennifer LeeFebruary 24 at 9:51 AM
Jennifer LeeFebruary 24 at 9:51 AM
// above & below
 Jennifer LeeFebruary 24 at 9:11 AM
Jennifer LeeFebruary 24 at 9:11 AM


An exercise that REALLY helped me understand how "noise" is visualized. Kept pushing th…
 Talia CottonFebruary 24 at 6:50 AM
Talia CottonFebruary 24 at 6:50 AM

 Sachi ChandiramaniFebruary 24 at 6:42 AM
Sachi ChandiramaniFebruary 24 at 6:42 AM

 Amber ChenFebruary 24 at 6:29 AM
Amber ChenFebruary 24 at 6:29 AM


 Dorothy CruzFebruary 24 at 5:37 AM
Dorothy CruzFebruary 24 at 5:37 AM
Fluffy Fluffy
 Jane LeeFebruary 24 at 5:29 AM
Jane LeeFebruary 24 at 5:29 AM
 Jane LeeFebruary 24 at 5:12 AM
Jane LeeFebruary 24 at 5:12 AM
 Sachi ChandiramaniFebruary 24 at 5:10 AM
Sachi ChandiramaniFebruary 24 at 5:10 AM
 Jane LeeFebruary 24 at 4:20 AM
Jane LeeFebruary 24 at 4:20 AM
 Jane LeeFebruary 24 at 4:03 AM
Jane LeeFebruary 24 at 4:03 AM


A shot at the treasure map challenge. And now for the journal entry: WHAT'S WORKING:<…
 Talia CottonFebruary 24 at 4:01 AM
Talia CottonFebruary 24 at 4:01 AM
 Talia CottonFebruary 24 at 1:54 AM
Talia CottonFebruary 24 at 1:54 AM



Help from: http://genekogan.com/code/p5js-…
 Sachi ChandiramaniFebruary 24 at 12:21 AM
Sachi ChandiramaniFebruary 24 at 12:21 AM
 Bateel SaberFebruary 24 at 12:07 AM
Bateel SaberFebruary 24 at 12:07 AM
Reiteration of one of my previous sketch
 Jonathan KhoFebruary 24 at 12:06 AM
Jonathan KhoFebruary 24 at 12:06 AM
Oompa Loompa?
 Jonathan KhoFebruary 23 at 11:33 PM
Jonathan KhoFebruary 23 at 11:33 PM
Kudos if y'all get the meme :D
 Jonathan KhoFebruary 23 at 11:19 PM
Jonathan KhoFebruary 23 at 11:19 PM


Noise & Texture & P5 & Laser Cutting & Tiles
 Danielle SobelFebruary 23 at 10:24 PM
Danielle SobelFebruary 23 at 10:24 PM

- Noise & Texture & P5
- Noise & Texture & P5 & Illustrator …
 Danielle SobelFebruary 23 at 10:20 PM
Danielle SobelFebruary 23 at 10:20 PM
 Bateel SaberFebruary 23 at 8:58 PM
Bateel SaberFebruary 23 at 8:58 PM
 Jonathan KhoFebruary 23 at 8:04 PM
Jonathan KhoFebruary 23 at 8:04 PM
W0rm
 Jonathan KhoFebruary 23 at 6:07 PM
Jonathan KhoFebruary 23 at 6:07 PM
 Jane LeeFebruary 23 at 5:21 AM
Jane LeeFebruary 23 at 5:21 AM
 Jonathan KhoFebruary 23 at 4:46 AM
Jonathan KhoFebruary 23 at 4:46 AM


Thanks Brinna for the advice!
 Dorothy CruzFebruary 23 at 4:00 AM
Dorothy CruzFebruary 23 at 4:00 AM
I don't know what this is. I used noise.
... or should I say, eye used noise?
 Talia CottonFebruary 23 at 3:28 AM
Talia CottonFebruary 23 at 3:28 AM
Chinese New Year Vibes
 Jonathan KhoFebruary 23 at 2:00 AM
Jonathan KhoFebruary 23 at 2:00 AM
Fixed up yesterday's shipwreck after getting some advices from Justin. The slow frame rate is…
 Amber ChenFebruary 23 at 1:59 AM
Amber ChenFebruary 23 at 1:59 AM

I tried to do something along these lines
 Dorothy CruzFebruary 22 at 11:21 PM
Dorothy CruzFebruary 22 at 11:21 PM


Part 2: Noise & Texture
 Danielle SobelFebruary 22 at 10:41 PM
Danielle SobelFebruary 22 at 10:41 PM


Part 1: Random & Texture
 Danielle SobelFebruary 22 at 10:36 PM
Danielle SobelFebruary 22 at 10:36 PM

 Bateel SaberFebruary 22 at 5:23 PM
Bateel SaberFebruary 22 at 5:23 PM
He mentioned the ellipse moved like a bee.
 Jennifer LeeFebruary 22 at 8:00 AM
Jennifer LeeFebruary 22 at 8:00 AM


 Amber ChenFebruary 22 at 5:13 AM
Amber ChenFebruary 22 at 5:13 AM
 Sachi ChandiramaniFebruary 22 at 4:15 AM
Sachi ChandiramaniFebruary 22 at 4:15 AM
ship(wreck)
 Amber ChenFebruary 21 at 9:51 PM
Amber ChenFebruary 21 at 9:51 PM
 Bateel SaberFebruary 21 at 6:50 PM
Bateel SaberFebruary 21 at 6:50 PM
 Bateel SaberFebruary 21 at 4:45 PM
Bateel SaberFebruary 21 at 4:45 PM
Static noise cloud
 Enayet KabirFebruary 21 at 2:22 AM
Enayet KabirFebruary 21 at 2:22 AM
Using randomGaussian and perlin noise to animate this pixelated pink blobby thing.
 Enayet KabirFebruary 21 at 2:19 AM
Enayet KabirFebruary 21 at 2:19 AM
Study using gaussian distribution of random numbers to separately determine the placement and opa…
 Enayet KabirFebruary 21 at 1:56 AM
Enayet KabirFebruary 21 at 1:56 AM

pillar design?
 Brinna ThomsenFebruary 21 at 1:32 AM
Brinna ThomsenFebruary 21 at 1:32 AM

 Dorothy CruzFebruary 21 at 1:25 AM
Dorothy CruzFebruary 21 at 1:25 AM
 Bateel SaberFebruary 20 at 10:14 PM
Bateel SaberFebruary 20 at 10:14 PM

Trying out noise to see what I can get.
 Dorothy CruzFebruary 20 at 6:45 PM
Dorothy CruzFebruary 20 at 6:45 PM
Peekaboo : )
 Amber ChenFebruary 19 at 6:11 AM
Amber ChenFebruary 19 at 6:11 AM
 Brinna ThomsenFebruary 19 at 1:51 AM
Brinna ThomsenFebruary 19 at 1:51 AM

Animating one of Laurent Grasso's paintings.
 Gabriel MesterFebruary 18 at 3:23 AM
Gabriel MesterFebruary 18 at 3:23 AM
 Brinna ThomsenFebruary 17 at 11:06 PM
Brinna ThomsenFebruary 17 at 11:06 PM
 Jane LeeFebruary 17 at 8:54 PM
Jane LeeFebruary 17 at 8:54 PM
 Jane LeeFebruary 17 at 8:42 PM
Jane LeeFebruary 17 at 8:42 PM
Experimented with parameters for Shiffmann's flocking sketch to learn more about forces and v…
 Kim KoehlerFebruary 17 at 8:37 PM
Kim KoehlerFebruary 17 at 8:37 PM

 Kim KoehlerFebruary 17 at 7:22 PM
Kim KoehlerFebruary 17 at 7:22 PM
colouring book // image credit : color this book: new york city, by abbi jacobson
 S. I.February 17 at 5:43 PM
S. I.February 17 at 5:43 PM
code credit to purin phanichphant // his work: http://purincess.co…
 S. I.February 17 at 5:15 PM
S. I.February 17 at 5:15 PM
Animal Slider
 Danielle SobelFebruary 17 at 4:48 PM
Danielle SobelFebruary 17 at 4:48 PM
manipulating parameters with face // mouth size = cube size // eyebrow height = color // made wit…
 S. I.February 17 at 4:42 PM
S. I.February 17 at 4:42 PM
sketch from last week + parameters
 S. I.February 17 at 4:41 PM
S. I.February 17 at 4:41 PM
 S. I.February 17 at 4:40 PM
S. I.February 17 at 4:40 PM
 Jennifer LeeFebruary 17 at 2:55 PM
Jennifer LeeFebruary 17 at 2:55 PM
sprinkles turned monet
 Jennifer LeeFebruary 17 at 2:21 PM
Jennifer LeeFebruary 17 at 2:21 PM
pixels
 Jennifer LeeFebruary 17 at 1:51 PM
Jennifer LeeFebruary 17 at 1:51 PM
A slider that controls the offset value of the sin wave. The white dots are not ellipses but the…
 Jennifer LeeFebruary 17 at 1:16 PM
Jennifer LeeFebruary 17 at 1:16 PM

A bit of a mess... Couldn't figure out how to position the lines properly. I tried rotating a…
 Sachi ChandiramaniFebruary 17 at 8:41 AM
Sachi ChandiramaniFebruary 17 at 8:41 AM


Took me a bit to figure this one out! https:…
 Sachi ChandiramaniFebruary 17 at 7:14 AM
Sachi ChandiramaniFebruary 17 at 7:14 AM

The parameters didn't fail but something else did. The three parameters are the HSB in the co…
 Amber ChenFebruary 17 at 6:30 AM
Amber ChenFebruary 17 at 6:30 AM
 Jonathan KhoFebruary 17 at 5:19 AM
Jonathan KhoFebruary 17 at 5:19 AM
 Jonathan KhoFebruary 17 at 5:11 AM
Jonathan KhoFebruary 17 at 5:11 AM
Spawn, my minions...
 Jonathan KhoFebruary 17 at 4:27 AM
Jonathan KhoFebruary 17 at 4:27 AM
Continuing to play with the pattern!
 Sachi ChandiramaniFebruary 17 at 3:09 AM
Sachi ChandiramaniFebruary 17 at 3:09 AM


🙌🏾 Face Generator V.2
 Dorothy CruzFebruary 17 at 3:00 AM
Dorothy CruzFebruary 17 at 3:00 AM
Not my best work...... just some experimentation with WebGL.. low-scale and unimpressive. On the…
 Talia CottonFebruary 17 at 1:42 AM
Talia CottonFebruary 17 at 1:42 AM
Added more shapes to the last sketch.
 Danielle SobelFebruary 17 at 1:27 AM
Danielle SobelFebruary 17 at 1:27 AM
 Danielle SobelFebruary 17 at 12:40 AM
Danielle SobelFebruary 17 at 12:40 AM
 Bateel SaberFebruary 17 at 12:09 AM
Bateel SaberFebruary 17 at 12:09 AM

WIP - It is taking forever, but I will get there.
 Dorothy CruzFebruary 16 at 9:50 PM
Dorothy CruzFebruary 16 at 9:50 PM
 Bateel SaberFebruary 16 at 5:55 PM
Bateel SaberFebruary 16 at 5:55 PM
 Danielle SobelFebruary 16 at 2:55 PM
Danielle SobelFebruary 16 at 2:55 PM
uses the newschool Neue font "as it was imagined" (so to speak) whereby the width of th…
 Talia CottonFebruary 16 at 6:10 AM
Talia CottonFebruary 16 at 6:10 AM
Applied sliders to a "Random" project
 Jonathan KhoFebruary 16 at 6:07 AM
Jonathan KhoFebruary 16 at 6:07 AM

Config your own Nic Cage Mona Lisa Face challenge // make your own at bit.ly/niccagemonalisa
… Talia CottonFebruary 16 at 5:38 AM
Talia CottonFebruary 16 at 5:38 AM

Face Generator(?) Inspiration: eugenia loli
 Jane LeeFebruary 16 at 4:47 AM
Jane LeeFebruary 16 at 4:47 AM
 Bateel SaberFebruary 16 at 3:50 AM
Bateel SaberFebruary 16 at 3:50 AM
 Bateel SaberFebruary 16 at 3:39 AM
Bateel SaberFebruary 16 at 3:39 AM
Revised version Baugasm
 Jane LeeFebruary 16 at 1:24 AM
Jane LeeFebruary 16 at 1:24 AM
The face modifying challenge. Uncheck nose box for maximum nightmare effect.
 Amber ChenFebruary 16 at 1:21 AM
Amber ChenFebruary 16 at 1:21 AM


You can choose between a Circle and a Line to be on the foreground. It lets you move the circle i…
 Dorothy CruzFebruary 15 at 7:22 PM
Dorothy CruzFebruary 15 at 7:22 PM


Moire Pattern #2, Now you can play around with line spacing and stroke weight.
 Dorothy CruzFebruary 15 at 6:07 PM
Dorothy CruzFebruary 15 at 6:07 PM
Everyone seems to be on to the Trump Theme.. :) I made a trumperator. Should have feathered the e…
 Kim KoehlerFebruary 15 at 5:15 PM
Kim KoehlerFebruary 15 at 5:15 PM

Remember the super old-school Etch a Sketch toy? Yea, digital version right here with similar lev…
 Amber ChenFebruary 15 at 5:47 AM
Amber ChenFebruary 15 at 5:47 AM
Inspired by trying to make fun of Trump :)
 Jonathan KhoFebruary 15 at 5:33 AM
Jonathan KhoFebruary 15 at 5:33 AM


Happy Valentines Day! Calculate the potential of you and your Bae using the Love Lab (TM). Caref…
 Talia CottonFebruary 15 at 4:43 AM
Talia CottonFebruary 15 at 4:43 AM
Took a little while to get the hang of setting the parameters. Got stuck trying to do the positio…
 Sachi ChandiramaniFebruary 15 at 4:33 AM
Sachi ChandiramaniFebruary 15 at 4:33 AM
 Bateel SaberFebruary 15 at 4:27 AM
Bateel SaberFebruary 15 at 4:27 AM
Snow!
 Danielle SobelFebruary 15 at 12:03 AM
Danielle SobelFebruary 15 at 12:03 AM

 Dorothy CruzFebruary 14 at 4:36 PM
Dorothy CruzFebruary 14 at 4:36 PM
Getting there! Just need a face change!
*Btw, GIFS don't work on regular img tags... j…
 Jonathan KhoFebruary 14 at 6:10 AM
Jonathan KhoFebruary 14 at 6:10 AM


Sine wave fun with parameters. Controlled by sliders on the side.
 Amber ChenFebruary 13 at 6:02 AM
Amber ChenFebruary 13 at 6:02 AM
click the link to see it // Included a slider that change color, mouseover show/hide, a start but…
 Jennifer LeeFebruary 13 at 2:31 AM
Jennifer LeeFebruary 13 at 2:31 AM


Dribbling. With changing size and speed. For some reason I can't get the slider of speed to w…
 Amber ChenFebruary 12 at 5:09 PM
Amber ChenFebruary 12 at 5:09 PM

windows 95 screensaver
- parameters that can be adjusted, built in p5.
s…
 Talia CottonFebruary 11 at 11:00 PM
Talia CottonFebruary 11 at 11:00 PM


 Dorothy CruzFebruary 10 at 8:02 PM
Dorothy CruzFebruary 10 at 8:02 PM
Was trying to get these "coral" pieces to flow from side to side (on mouse move) like a…
 Sachi ChandiramaniFebruary 10 at 6:47 PM
Sachi ChandiramaniFebruary 10 at 6:47 PM
Acceptable in the 80's
 Gabriel MesterFebruary 10 at 6:40 PM
Gabriel MesterFebruary 10 at 6:40 PM
 Jane LeeFebruary 10 at 12:03 PM
Jane LeeFebruary 10 at 12:03 PM
 Jane LeeFebruary 10 at 11:56 AM
Jane LeeFebruary 10 at 11:56 AM
 Jane LeeFebruary 10 at 11:17 AM
Jane LeeFebruary 10 at 11:17 AM

Make your own Baugasm poster
 Jane LeeFebruary 10 at 10:38 AM
Jane LeeFebruary 10 at 10:38 AM
 Jane LeeFebruary 10 at 9:01 AM
Jane LeeFebruary 10 at 9:01 AM
Look at it flying away!
 Gabriel MesterFebruary 10 at 7:13 AM
Gabriel MesterFebruary 10 at 7:13 AM
Missed a face.
Now this is how I TRULY feel about art school...
 Jonathan KhoFebruary 10 at 6:29 AM
Jonathan KhoFebruary 10 at 6:29 AM
They call me Roth(kho). I tried...
 Jonathan KhoFebruary 10 at 6:21 AM
Jonathan KhoFebruary 10 at 6:21 AM
Web GL
 Gabriel MesterFebruary 10 at 6:06 AM
Gabriel MesterFebruary 10 at 6:06 AM


Channelling Rothko effort 1.
 Talia CottonFebruary 10 at 6:02 AM
Talia CottonFebruary 10 at 6:02 AM
 Jennifer LeeFebruary 10 at 5:08 AM
Jennifer LeeFebruary 10 at 5:08 AM
All about them screensavor vibes...
 Jonathan KhoFebruary 10 at 4:48 AM
Jonathan KhoFebruary 10 at 4:48 AM
Will this damage my computer? It's starting to lag...
 Jonathan KhoFebruary 10 at 3:27 AM
Jonathan KhoFebruary 10 at 3:27 AM

CLICK THE VIDEO If you choose to not fill your GPU(Graphics Processing Unit) with any media when…
 Kim KoehlerFebruary 10 at 3:08 AM
Kim KoehlerFebruary 10 at 3:08 AM
 Jennifer LeeFebruary 10 at 3:01 AM
Jennifer LeeFebruary 10 at 3:01 AM


An "attempt" competitive puzzle game inspired by the random game level mentioned in cla…
 Amber ChenFebruary 10 at 2:57 AM
Amber ChenFebruary 10 at 2:57 AM


finally.
THE SOLUTION! --> I wasn't aware of the push() and pop() functions in p5. I…
 Talia CottonFebruary 10 at 2:40 AM
Talia CottonFebruary 10 at 2:40 AM

hyperspace
 Jennifer LeeFebruary 10 at 2:34 AM
Jennifer LeeFebruary 10 at 2:34 AM

Did this with BUNCH of help! But I was able to replicate my animated tile from first week.
 Dorothy CruzFebruary 10 at 2:27 AM
Dorothy CruzFebruary 10 at 2:27 AM

 Jennifer LeeFebruary 10 at 1:48 AM
Jennifer LeeFebruary 10 at 1:48 AM


Loading...
 Dorothy CruzFebruary 10 at 1:26 AM
Dorothy CruzFebruary 10 at 1:26 AM


floating forest! (attempt #2. deep breath...) with some help from "The Nature of Code || Dan…
 Talia CottonFebruary 10 at 1:03 AM
Talia CottonFebruary 10 at 1:03 AM

When you click the screen, only one star-thing remains.
 Sachi ChandiramaniFebruary 10 at 12:25 AM
Sachi ChandiramaniFebruary 10 at 12:25 AM
i dont know what i did wrong (mondrian + disco ?)
 Sanie IrsayFebruary 10 at 12:04 AM
Sanie IrsayFebruary 10 at 12:04 AM
Mondrian Interactivity
 Danielle SobelFebruary 9 at 11:36 PM
Danielle SobelFebruary 9 at 11:36 PM
Mondrian Interactivity
 Danielle SobelFebruary 9 at 11:35 PM
Danielle SobelFebruary 9 at 11:35 PM


Disco ball
 Dorothy CruzFebruary 9 at 9:36 PM
Dorothy CruzFebruary 9 at 9:36 PM


Random gradient generator, both static and dynamic
 Talia CottonFebruary 9 at 9:00 PM
Talia CottonFebruary 9 at 9:00 PM
Snow day today. This sketch builds up in a few layers.
First, It draws a layer of ground s…
 Justin BakseFebruary 9 at 8:51 PM
Justin BakseFebruary 9 at 8:51 PM

Shout out to my awesome classmates! I was inspired by Jonathan and Danielle's pointillism pos…
 Sachi ChandiramaniFebruary 9 at 7:37 PM
Sachi ChandiramaniFebruary 9 at 7:37 PM
1st mondrian attempt - not exactly true to his work yet + needs more obvious texture // used exam…
 Sanie IrsayFebruary 9 at 6:15 PM
Sanie IrsayFebruary 9 at 6:15 PM
Lots of help and inspiration from the link above!
 Sachi ChandiramaniFebruary 9 at 5:06 PM
Sachi ChandiramaniFebruary 9 at 5:06 PM
Random Walker, Take two.
 Danielle SobelFebruary 9 at 5:00 AM
Danielle SobelFebruary 9 at 5:00 AM

Randomizing the speed for circles to shrink with min vs. max rate.
 Amber ChenFebruary 9 at 4:47 AM
Amber ChenFebruary 9 at 4:47 AM


This was the first failed attempt at a fractal forest. Method: First define number of trees. (ran…
 Talia CottonFebruary 9 at 3:41 AM
Talia CottonFebruary 9 at 3:41 AM
 Bateel SaberFebruary 8 at 11:49 PM
Bateel SaberFebruary 8 at 11:49 PM


I played around with min and max.
 Dorothy CruzFebruary 8 at 11:30 PM
Dorothy CruzFebruary 8 at 11:30 PM
 Bateel SaberFebruary 8 at 7:07 PM
Bateel SaberFebruary 8 at 7:07 PM


This is my first shot at doing the "Kazimir Malevich Challange".
The video is my…
 Kim KoehlerFebruary 8 at 4:37 PM
Kim KoehlerFebruary 8 at 4:37 PM

 Amber ChenFebruary 8 at 6:20 AM
Amber ChenFebruary 8 at 6:20 AM
 Jennifer LeeFebruary 8 at 5:59 AM
Jennifer LeeFebruary 8 at 5:59 AM
clicking add random points (Background gif from google - can't find the creator...)
 Jane LeeFebruary 8 at 5:40 AM
Jane LeeFebruary 8 at 5:40 AM
same code, except now it follows the mouse (while still moving randomly around it) + arrow keys c…
 Sanie IrsayFebruary 8 at 3:46 AM
Sanie IrsayFebruary 8 at 3:46 AM


again using brownian motion // used example code by justin bakse
 Sanie IrsayFebruary 8 at 3:44 AM
Sanie IrsayFebruary 8 at 3:44 AM
Random Walker (Pink).. Click on the thumbnail to see the whole video.
 Danielle SobelFebruary 8 at 2:58 AM
Danielle SobelFebruary 8 at 2:58 AM
 Gabriel MesterFebruary 8 at 12:55 AM
Gabriel MesterFebruary 8 at 12:55 AM
 Bateel SaberFebruary 8 at 12:47 AM
Bateel SaberFebruary 8 at 12:47 AM


Random color, sizes, and opacity.
 Dorothy CruzFebruary 7 at 11:44 PM
Dorothy CruzFebruary 7 at 11:44 PM

 Sanie IrsayFebruary 7 at 9:19 PM
Sanie IrsayFebruary 7 at 9:19 PM

manipulating the brownian motion code in the study examples (thank you Justin Bakse) to create tw…
 Sanie IrsayFebruary 7 at 9:15 PM
Sanie IrsayFebruary 7 at 9:15 PM
Oh my god... #Hillaryous
 Jonathan KhoFebruary 7 at 5:03 PM
Jonathan KhoFebruary 7 at 5:03 PM
How I feel in art school...
 Jonathan KhoFebruary 7 at 7:21 AM
Jonathan KhoFebruary 7 at 7:21 AM
 Bateel SaberFebruary 7 at 5:11 AM
Bateel SaberFebruary 7 at 5:11 AM


Woven Textile
 Dorothy CruzFebruary 6 at 10:14 PM
Dorothy CruzFebruary 6 at 10:14 PM
 Danielle SobelFebruary 6 at 2:18 PM
Danielle SobelFebruary 6 at 2:18 PM
 Danielle SobelFebruary 6 at 2:12 PM
Danielle SobelFebruary 6 at 2:12 PM


Predetermined fates.
 Talia CottonFebruary 6 at 4:35 AM
Talia CottonFebruary 6 at 4:35 AM
 Bateel SaberFebruary 6 at 4:28 AM
Bateel SaberFebruary 6 at 4:28 AM

Trying to create depth by using different shades of grey and different circle diameters.
 Gabriel MesterFebruary 6 at 4:21 AM
Gabriel MesterFebruary 6 at 4:21 AM Danielle SobelFebruary 6 at 3:31 AM
Danielle SobelFebruary 6 at 3:31 AM
P5
 Danielle SobelFebruary 6 at 2:29 AM
Danielle SobelFebruary 6 at 2:29 AM


Random Herd Generator. Running into some issues which a shaved sheep pops out every once in a whi…
 Amber ChenFebruary 6 at 2:04 AM
Amber ChenFebruary 6 at 2:04 AM

An asemic composition made of pieces of type.
 Gabriel MesterFebruary 5 at 10:42 PM
Gabriel MesterFebruary 5 at 10:42 PM
 Sanie IrsayFebruary 5 at 8:27 PM
Sanie IrsayFebruary 5 at 8:27 PM

 Amber ChenFebruary 5 at 6:07 AM
Amber ChenFebruary 5 at 6:07 AM

Inspiration and help:
 Sachi ChandiramaniFebruary 5 at 1:40 AM
Sachi ChandiramaniFebruary 5 at 1:40 AM
 Lauren DonohueFebruary 3 at 8:12 PM
Lauren DonohueFebruary 3 at 8:12 PM
 Sachi ChandiramaniFebruary 3 at 8:19 AM
Sachi ChandiramaniFebruary 3 at 8:19 AM

Grow your cactus
 Jane LeeFebruary 3 at 7:26 AM
Jane LeeFebruary 3 at 7:26 AM

 Jane LeeFebruary 3 at 6:49 AM
Jane LeeFebruary 3 at 6:49 AM


Revised version of previous tile set. Attempt to make some glyphs and characters.
 Amber ChenFebruary 3 at 6:38 AM
Amber ChenFebruary 3 at 6:38 AM

Pixel monster
 Terricka JohnsonFebruary 3 at 6:02 AM
Terricka JohnsonFebruary 3 at 6:02 AM
 Sachi ChandiramaniFebruary 3 at 5:43 AM
Sachi ChandiramaniFebruary 3 at 5:43 AM

Another trial.
 Dorothy CruzFebruary 3 at 4:50 AM
Dorothy CruzFebruary 3 at 4:50 AM
 Jennifer LeeFebruary 3 at 3:40 AM
Jennifer LeeFebruary 3 at 3:40 AM
 Jennifer LeeFebruary 3 at 3:39 AM
Jennifer LeeFebruary 3 at 3:39 AM

 Bateel SaberFebruary 3 at 3:23 AM
Bateel SaberFebruary 3 at 3:23 AM
 Jennifer LeeFebruary 3 at 3:21 AM
Jennifer LeeFebruary 3 at 3:21 AM


Random Rotation of one single square to create connected circles. Check out the codepen!
 Talia CottonFebruary 3 at 2:58 AM
Talia CottonFebruary 3 at 2:58 AM

1000
 Aaron LeeFebruary 3 at 2:43 AM
Aaron LeeFebruary 3 at 2:43 AM


When I was living in the bay area, I used to take pictures from the BART platforms I would stop a…
 Lauren DonohueFebruary 3 at 2:34 AM
Lauren DonohueFebruary 3 at 2:34 AM
Didn't know it would turn out to be this disgusting... Yea... they are my fat fingers
 Jonathan KhoFebruary 3 at 1:50 AM
Jonathan KhoFebruary 3 at 1:50 AM
Patterned Paper
 Danielle SobelFebruary 3 at 1:33 AM
Danielle SobelFebruary 3 at 1:33 AM


الحب (Love)
 Jonathan KhoFebruary 3 at 1:25 AM
Jonathan KhoFebruary 3 at 1:25 AM

 Jonathan KhoFebruary 3 at 12:33 AM
Jonathan KhoFebruary 3 at 12:33 AM


I tried.
 Dorothy CruzFebruary 2 at 9:50 PM
Dorothy CruzFebruary 2 at 9:50 PM
 Danielle SobelFebruary 2 at 4:00 PM
Danielle SobelFebruary 2 at 4:00 PM
 Bateel SaberFebruary 2 at 6:37 AM
Bateel SaberFebruary 2 at 6:37 AM
 Brinna ThomsenFebruary 2 at 4:53 AM
Brinna ThomsenFebruary 2 at 4:53 AM

 Jane LeeFebruary 2 at 4:29 AM
Jane LeeFebruary 2 at 4:29 AM


Attempted typography with numbers and Chinese character for 2nd and 3rd image
 Amber ChenFebruary 2 at 3:45 AM
Amber ChenFebruary 2 at 3:45 AM


Tiles from a close up of a half-toned color.
 Gabriel MesterFebruary 2 at 3:05 AM
Gabriel MesterFebruary 2 at 3:05 AM
 Jane LeeFebruary 2 at 2:21 AM
Jane LeeFebruary 2 at 2:21 AM


This one is called: A really great start to something that has potential to turn into something.<…
 Talia CottonFebruary 2 at 1:46 AM
Talia CottonFebruary 2 at 1:46 AM


 Gabriel MesterFebruary 2 at 12:25 AM
Gabriel MesterFebruary 2 at 12:25 AM


 Dorothy CruzFebruary 1 at 10:31 PM
Dorothy CruzFebruary 1 at 10:31 PM
Pink Tiles Using P5
 Danielle SobelFebruary 1 at 8:54 PM
Danielle SobelFebruary 1 at 8:54 PM


Continuation of Tile Set #4
 Aaron LeeFebruary 1 at 7:09 AM
Aaron LeeFebruary 1 at 7:09 AM


Tile Set # 4 Made a tile set from the inspired wang tiles. Used processing to create the layout.…
 Aaron LeeFebruary 1 at 7:07 AM
Aaron LeeFebruary 1 at 7:07 AM
 Jane LeeFebruary 1 at 4:59 AM
Jane LeeFebruary 1 at 4:59 AM



 Amber ChenFebruary 1 at 3:02 AM
Amber ChenFebruary 1 at 3:02 AM

 Jonathan KhoFebruary 1 at 12:06 AM
Jonathan KhoFebruary 1 at 12:06 AM
 Bateel SaberJanuary 31 at 11:26 PM
Bateel SaberJanuary 31 at 11:26 PM

 Sanie IrsayJanuary 31 at 9:25 PM
Sanie IrsayJanuary 31 at 9:25 PM


 Sanie IrsayJanuary 31 at 9:21 PM
Sanie IrsayJanuary 31 at 9:21 PM
#tiles
 Kim KoehlerJanuary 31 at 8:14 PM
Kim KoehlerJanuary 31 at 8:14 PM
 Bateel SaberJanuary 31 at 7:39 AM
Bateel SaberJanuary 31 at 7:39 AM
Close ups of typography that I scanned and moved around to get a glitchy effect. A failed attempt…
 Sachi ChandiramaniJanuary 31 at 5:08 AM
Sachi ChandiramaniJanuary 31 at 5:08 AM

3D set of 64 cubes... Playing with calculating the number of subsets of a set with n elements. Ca…
 Talia CottonJanuary 31 at 4:29 AM
Talia CottonJanuary 31 at 4:29 AM
wang tiles attempt to write "HEY"
 Jennifer LeeJanuary 31 at 4:13 AM
Jennifer LeeJanuary 31 at 4:13 AM

scales
 Brinna ThomsenJanuary 31 at 3:07 AM
Brinna ThomsenJanuary 31 at 3:07 AM
.gif tiles
 Amber ChenJanuary 30 at 11:30 PM
Amber ChenJanuary 30 at 11:30 PM


Triangles
 Dorothy CruzJanuary 30 at 8:54 PM
Dorothy CruzJanuary 30 at 8:54 PM
C O M P
 Sanie IrsayJanuary 30 at 6:05 AM
Sanie IrsayJanuary 30 at 6:05 AM

 Jonathan KhoJanuary 30 at 5:59 AM
Jonathan KhoJanuary 30 at 5:59 AM


//cut, folded, scanned paper //rearranged into tiles
 Sanie IrsayJanuary 30 at 5:51 AM
Sanie IrsayJanuary 30 at 5:51 AM

 Amber ChenJanuary 30 at 5:31 AM
Amber ChenJanuary 30 at 5:31 AM

 Aaron LeeJanuary 30 at 4:26 AM
Aaron LeeJanuary 30 at 4:26 AM

Made with After Effects.
 Dorothy CruzJanuary 30 at 12:32 AM
Dorothy CruzJanuary 30 at 12:32 AM


 Bateel SaberJanuary 29 at 10:59 PM
Bateel SaberJanuary 29 at 10:59 PM
 Danielle SobelJanuary 29 at 3:57 PM
Danielle SobelJanuary 29 at 3:57 PM
Mindfulness Drawing
 Danielle SobelJanuary 29 at 3:58 AM
Danielle SobelJanuary 29 at 3:58 AM

 Sachi ChandiramaniJanuary 29 at 3:56 AM
Sachi ChandiramaniJanuary 29 at 3:56 AM


 Aaron LeeJanuary 29 at 2:13 AM
Aaron LeeJanuary 29 at 2:13 AM


1st image by JONATHAN KHO
 Sanie IrsayJanuary 27 at 11:32 PM
Sanie IrsayJanuary 27 at 11:32 PM

 Talia CottonJanuary 27 at 11:30 PM
Talia CottonJanuary 27 at 11:30 PM
Tile set by SACHI CHANDIRAMANI
 Amber ChenJanuary 27 at 11:29 PM
Amber ChenJanuary 27 at 11:29 PM

 Kim KoehlerJanuary 27 at 11:29 PM
Kim KoehlerJanuary 27 at 11:29 PM

 Gabriel MesterJanuary 27 at 11:28 PM
Gabriel MesterJanuary 27 at 11:28 PM
 Sachi ChandiramaniJanuary 27 at 11:27 PM
Sachi ChandiramaniJanuary 27 at 11:27 PM
 Enayet KabirJanuary 27 at 11:27 PM
Enayet KabirJanuary 27 at 11:27 PM
 Danielle SobelJanuary 27 at 11:26 PM
Danielle SobelJanuary 27 at 11:26 PM
 Jane LeeJanuary 27 at 11:26 PM
Jane LeeJanuary 27 at 11:26 PM
Tiles designed by Jane Lee.
 Dorothy CruzJanuary 27 at 11:23 PM
Dorothy CruzJanuary 27 at 11:23 PM
 Bateel SaberJanuary 27 at 11:22 PM
Bateel SaberJanuary 27 at 11:22 PM
 Jonathan KhoJanuary 27 at 11:22 PM
Jonathan KhoJanuary 27 at 11:22 PM
Used Kim Koehler's tiles
 Aaron LeeJanuary 27 at 11:22 PM
Aaron LeeJanuary 27 at 11:22 PM

 Chao TuJanuary 27 at 11:22 PM
Chao TuJanuary 27 at 11:22 PM
 Jennifer LeeJanuary 27 at 11:22 PM
Jennifer LeeJanuary 27 at 11:22 PM
Sierpinski'd
 Justin BakseJanuary 27 at 11:06 PM
Justin BakseJanuary 27 at 11:06 PM
 Justin BakseJanuary 23 at 5:53 PM
Justin BakseJanuary 23 at 5:53 PM